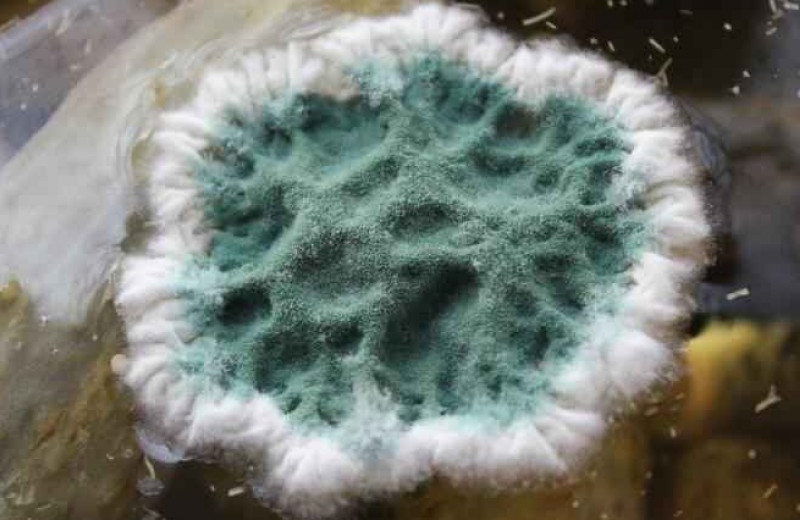

Как сделать плесень: Как выращивать плесень в домашних условиях?
Плесень на хлебе . Как ее вырастить в домашних условиях?
Очень часто на биологических факультетах в вузах (да и в обычной школе) задают весьма необычайное домашнее задание – вырастить плесень на хлебе. И делается это далеко не ради забавы. А для эффективной учебы учащихся и ради биологического эксперимента. Именно поэтому очень часто можно встретить вопрос о том, как вырастить на хлебе плесень.
Что же это такое?
Перед тем как приступить к решению поставленной задачи, необходимо четко понимать, над чем придется работать. И для этого следует разобраться в том, что же такое плесень. В первую очередь это микроскопический гриб. Многие считают, что плесень – это бактерия. Но проведенные исследования доказали, что это все же гриб, плодовое тело которого способно развиваться практически в любой питательной среде. Для выращивания плесени можно использовать не только хлеб, но и другие продукты. Главное — создать оптимальные условия для этого. Итак, как сделать плесень на хлебе в кратчайшие сроки?
Виды плесени
На данный момент известно несколько разновидностей микроскопических грибков. К ним относится черная, желтая и серая плесень. Некоторые из видов считаются полезными, например красная, белая и голубая. С помощью этой плесени изготавливают достаточно вкусные сыры. При этом подобный продукт обладает множеством полезных свойств. В первую очередь в составе такого сыра имеется белок, кальций и витамины группы В. Употребление таких продуктов положительным образом сказывается на состоянии кровеносной системы, а также улучшает работу ЖКТ. Однако кушать сыры с плесенью нельзя кормящим и беременным женщинам.
Почему возникает плесень?
В быту человек постоянно сталкивается со всевозможными видами плесени на совершенно разных продуктах, а также на вещах. Образуется подобный налет особым видом грибка, полезные качества которого человек научился применять в благих целях. Некоторые компоненты используются при изготовления определенной группы медикаментов и продуктов. Стоит отметить, что плесень может развиваться в условиях, которые оптимально подходят для человека. Для микроскопического грибка важно наличие питательной среды. А дальше дело стоит за малым.
Почему именно хлеб?
Плесень на хлебе – это достаточно распространенное явление. Даже у самой щепетильной хозяйки спустя некоторое время продукт поражается подобным грибком. И это не показатель неопрятности. На самом деле для развития микроскопического грибка нужна питательная среда, которая богата углеводами, а также тепло. Хлеб – это идеальный продукт для роста плесени. Ведь он богат углеводами и хранится в тепле.
Если в доме отсутствует хлеб, то для выращивания плесени можно использовать фрукты и картофель.
Каким должен быть хлеб?
Так как вырастить на хлебе плесень нужно быстро, то стоит заранее подготовить все необходимое. Для создания оптимальной среды для роста микроскопического грибка совсем не обязательно покупать свежую выпечку. Для этого идеально подойдет даже старый кусочек хлеба. При этом многие специалисты утверждают, что для выращивания плесени лучше использовать белую выпечку: батон или булочку.
Чтобы ускорить процесс, необходимо поместить продукт в помещение с влажным и теплым воздухом. А чтобы замедлить рост микроскопического грибка, стоит перенести кусочек хлеба в сухую и холодную среду. Сам же процесс состоит всего из нескольких этапов.
Этап первый
Плесень на хлебе, фото которой можно увидеть ниже, появляется спустя сутки, если кусочек белого хлеба смочить немного в воде, а затем поместить в полиэтиленовый пакет. При этом не стоит плотно его завязывать. В данном случае пакет должен быть прозрачным. Подобная структура материала позволит увидеть, появилась ли плесень на хлебе и какого она цвета.
Прежде всего споры поражают корку мучного изделия, а уже позже сам мякиш. Если на хлебе появилась хотя бы маленькая трещинка, то именно с этого места продукт начнет плесневеть, постепенно переходя на внутреннюю область. В этой части влажность более высокая, микроскопический грибок распространяется намного быстрее.
Споры плесени способствуют скорейшему разложению мякиши. В результате этого хлеб теряет свой приятный аромат и вкус. Более плотная корка на продукте не позволяет грибку проникнуть внутрь. Наверное, многие замечали, что хлеб, продаваемый в пакетах, очень долго не плесневеет. Все дело в том, что данный продукт содержит консерванты, которые не позволяют грибку развиваться. Поэтому для эксперимента не стоит брать такой продукт.
Этап второй
Так как сделать плесень на хлебе при интенсивном освещении очень сложно, пакет с продуктом нужно поместить в темное место. Первые споры микроскопического грибка появятся уже через сутки. Однако увидеть их невооруженным глазом будет достаточно сложно. Обычно это еле заметные ниточки, которые спрятаны между пор хлеба.
Спустя несколько суток плесень на хлебе станет более заметной. Изначально микроскопический грибок будет проявляться практически незаметными светлыми пятнами. Постепенно они будут темнеть и увеличиваться в размерах, пока поверхность хлеба не будет скрыта под слоем плесени.
На этом рост грибка не заканчивается. Спустя еще несколько суток появится зеленый налет, который постепенно будет менять свой оттенок. В итоге образуется черная плесень на хлебе. Подобное явление указывает на то, что микроскопический грибок в созданных условиях чувствует себя прекрасно и решил увеличить колонию при помощи собственных спор.
Можно ли кушать продукты с плесенью
Даже белая плесень на хлебе – это яд. Любой продукт с микроскопическими грибками следует сразу же выбросить. Самой опасной является желтая плесень. Казалось бы, безобидный грибок. Но на самом деле плесень способна вызвать рост раковых новообразований.
Конечно, сыр с плесенью — исключение. К тому же микроскопический грибок в этом случае готовят специально, и он является благородным. Однако кушать обычный сыр, покрытый плесенью, опасно.
Что делать, если съел продукт с плесенью
Итак, что делать, если нечаянно съел хлеб с плесенью? Многие к подобному относятся равнодушно. Но не стоит смотреть на подобное сквозь пальцы. Конечно, от подобного дополнения в рационе человек не умрет. Но все же это считается отравлением. В первую очередь от этого страдает печень.
Обычно после употребления продуктов с плесенью врачи рекомендуют выпить обычный активированный уголь. Дозировка препарата зависит от веса. На каждые десять килограмм нужно выпить одну таблетку.
Если же съедено большое количество испорченного продукта, то следует выпить слабый раствор марганцовки. Это позволит очистить желудок. Для подстраховки не лишним будет пропить курс препарата, который способствует восстановлению клеток печени.
В заключение
Плесень на хлебе, фото под микроскопом которой поражают своей красотой, является признаком того, что продукт чист в экологическом плане и был пригоден для употребления. Стоит отметить, что подобные микроскопические грибки не размножаются в загрязненной среде. При проведении эксперимента следует учесть, что обычный пресных хлеб покрывается плесенью намного быстрее, чем мучные сладкие изделия. Это объясняется тем, что в подобных продуктах содержатся консерванты. Подобные компоненты замедляют развитие грибка.
Не стоит забывать, что плесень вредит нашему организму. Ученые нашли в продуктах, покрытых данным грибком, более 100 токсических соединений. Употребление подобной пищи может привести к серьезным проблемам. Токсины, попавшие в организм, могут долгое время не проявляться. Однако спустя несколько десятилетий именно они будут главной причиной интенсивного роста раковых новообразований. Стоит отметить, что даже термическая обработка не избавляет продукты от вредных соединений. Поэтому продукты, покрытые плесенью, необходимо выбрасывать.
Как вырастить плесень для сыра в домашних условиях
Содержание
- Как вырастить плесень на сыре
- Сыры с белой плесенью
- Сыры с голубой плесенью
- Наиболее распространенные проблемы
- Белая плесень
- Голубая плесень
- Итог
Выращивать плесень на сырной культуре можно и в домашних условиях. Подобный продукт отличается мягкой структурой и резким, сильным вкусом. Некоторые технологии позволяют выращивать плесень быстро, однако большинство сортов созревают не менее месяца.
Как вырастить плесень на сыре
Выращивание сыров с плесенью сопряженно с определенными трудностями. На сегодняшний день существуют безвредные штаммы бактерий, выведенные в лабораториях, однако подобная плесень также может быть токсичной. Важно четко придерживаться рецептуре и не нарушать технологию приготовления продукта.
Сыры с белой плесенью
Для получения белого налета плесени используют два тип бактерий – Penicillium candidum и Geotrichum candidum. Первый тип подходит для приготовления сыров на основе коровьего молока.
Штамм PC покрывает продукт цельной пушистой плесенью. Сама масса под воздействием бактерии становиться мягкой и тягучей.
Штамм GEO используют для приготовления продукции из козьего молока. Также данный тип плесени часто вмешивают в основу для подготовки сырной массы к росту Penicillium candidum. Таким образом готовится сорт Камамбер.
Для приготовления сыра с белой плесенью потребуется:
- молоко – 8 л;
- закваска, содержащая мезофильные микроэлементы – 3 г;
- бактерия Penicillium candidum в виде сухого порошка – 1 г;
- хлорид кальция – 3 г;
- жидкий коагулянт – 3 г;
- каменная соль – 50 г.
Основу нагревают на медленном огне и снимают до начала кипения. В молоко добавляют мезофильный фермент и бактерию белой плесени. Следует подождать в течение 15 минут, пока жидкость свернется, после чего в смесь добавляют хлористый кальций и сычужную закваску.
Будущий сыр выкладывают в специальную форму и помещают в контейнер на 4 часа. За этот период необходимо дважды перевернуть заготовку. После массу солят равномерно по всей поверхности и вновь оставляют в контейнере.
Емкость должная находиться в холодном и влажном месте – от 6 до 10°С при 90% влажности. Масса следует ежедневно переворачивать для удаления лишней жидкости. Стекшую сыворотку необходимо сливать из контейнера. Через неделю Penicillium candidum начнет появляться на поверхности сыра.
На 14 день после начала эксперимента плесень полностью покроет продукт, после чего массу оборачивают пергаментом. Сыр будет полностью готов спустя 5 недель.
Сыры с голубой плесенью
Технология приготовления голубых сортов не сильно отличается от рецептов сыра с белой плесенью. Разница состоит в условиях созревания и обязательном прессовании продукта.
Существует два способа приготовить сыр с голубой плесенью – введение Penicillium Roqueforti в момент созревание с помощью игл или же добавление штамма на стадии приготовления основы.
Дома предпочтительнее использовать второй метод, т.к. он проще. Требующиеся ингредиенты:
- молоко – 8 л;
- мезофильная закваска – 3 г;
- сухой штамм PR – одна шестнадцатая чайно ложки;
- хлорид кальция – 3 г;
- коагулянт в жидком виде – 3 г;
- соль – 30 г;
- вода – 50 мл.
Основу подогревают до 62°С, после чего дают остыть до 30°С. В молоко добавляют бактерию Penicillium Roqueforti и закваску, содержащую мезофильные микроэлементы. Смесь оставляют настояться под крышкой в течение получаса.
Отдельно замешивают раствор из воды и хлорида кальция, после чего добавляют в основу. Массу вымешивают в течение 10 минут и оставляют на полтора часа.
Сгусток нарезают кубиками и помещают в марлю, чтобы дать стечь жидкости. Будущий сыр кладут под деревянную доску и устанавливают груз в 4 кг. Под прессом продукт должен провести 10 часов.
Образовавшуюся головку измельчают, пересаливают и вновь прессуют. В первые сутки сгусток необходимо переворачивать каждые 6 часов, на вторые – один раз в 12 часов.
На третий день сыр заворачивают в специальную бумагу и сушат 24 часа. В головке делают ряд отверстий и помещают массу в теплое и очень влажное место – выше 12°С при 95% влаги в воздухе. Сыр вызревает 30 дней.
Наиболее распространенные проблемы
Выращивание бактерии на сыре в домашних условиях порой сопровождается трудностями. Характер проблем зависит от вида бактерий.
Белая плесень
Вид PC требует строгого контроля за ростом, в противном случае сыр станет не пригоден к употреблению. Часто новички используют для приготовления дикий тип GEO, который содержится в непастеризованном молоке. Однако развитие подобного штамма невозможно предугадать – бактерии могут наполнить продукт токсинами, делая сырную массу небезопасной к употреблению.
Сыр пахнет аммиаком
Следует учесть, что легкий аромат аммиака не считается изъяном, если речь идет о продуктах с белой плесенью. Однако сильный и резкий запах является основанием для пересмотра действующей технологии. Существует несколько причин данного явления:
- Несоблюдение температурного режима. Для улучшения качества продукции следует охладить емкость для созревания на пару градусов.
- Большое содержание жидкости в сырной массе. Избежать данной проблемы можно путем нарезания и вымешивания продукта
- Активный рост Penicillium candidum.
Предотвратить подобное поможет соблюдение пропорций, указанных на пакете препарата. Для исправления ситуации следует обернуть кисломолочную массу в бумагу и оставить продукт созревать при температуре в 6 градусов.
Причина чрезмерной активности бактерий и резкого запаха аммиака порой кроется в некачественном штамме. В подобном случае сыр нельзя употреблять в пищу.
Сыр горчит
Горечь чаще возникает в созревших и размягченных частях массы. Причинами данного явления служат:
- Высокая температура. Горький вкус в подобной ситуации дает бактерия GEO. Предотвратить порчу продукции можно, снизив температуру до 6°С.
- Маслянокислая палочка. Данная бактерия усиливает брожение сырной массы и придает продукту прогорклый привкус. Избежать подобной ситуации поможет защитный фермент RC-14.
- Передозировка кальциевой соли соляной кислоты или Geotrichum candidum.
Причиной появления горечи также служит некачественное молоко. Если корова питалось силосом или болела на момент дойки, это отразится на вкусовых качествах сыра.
Сыр растекается
Порой сыр излишне размягчается под влиянием Penicillium candidum и перестает держать форму. Подобная ситуация может возникать в таких случаях:
- Большой процент влаги в составе сыра.
- Перезревание продукта.
Следует учесть, что некоторые сорта подразумевают излишнюю текучесть. К ним относят Камамбер и Бри.
Слишком твердая текстура сыра
Частичная или полная твердость продукта является признаком нарушения технологии приготовления. Причинами служат:
- Сырная масса еще не дозрела. Не рекомендуется также раскрывать емкость раньше срока созревания – данное действие негативно отразится на активности бактерии.
- Недостаток жидкости в структуре массы. Чтобы избежать данной ситуации, следует уменьшить количество вымешиваний сыра на подготовительном этапе и отказаться от нарезки продукта.
- Отсутствие активности у бактерий. Перед началом работы необходимо проверить срок годности препаратов.
Данные причины также вызывают излишнюю творожистость сыра.
Неровный слой плесени
Внешне подобный изъян проявляется в виде очагов разрастания плесени. Данная ситуация возникает в таких случаях:
- Соль неравномерно распределена по поверхности массы. В местах скопления компонента плесень растет хуже.
- Сырная масса касается жидкости в нижней части поддона. Следует переворачивать продукт, чтобы избежать длительного контакта со стекшей влагой.
- Неравномерное распределение бактерий по поверхности продукта.
Плохой рост Penicillium candidum иногда объясняется наличием антибиотиков в молочных заготовках. Лекарственные препараты, которые дают животным, замедляют активность бактерий.
Также темп роста существенно снижает повышенная кислотность. Чтобы улучшить качество сыра, в данном случае применяют оба типа растворов белой плесени – GEO снижает кислотность и не конфликтует с PC.
Слишком толстая корка из белой плесени
Излишние количество Penicillium candidum приводит к отторжению основной части сыра от корки и размягчению массы до жидкого состояния.
Чтобы избежать данной проблемы, следует при переворачивании фиксировать поверхность сыра рукой. Когда корка Penicillium candidum приобретет однородную структуру, массу оборачивают специально бумагой и помещают в прохладное место.
Белая плесень стала розовой
Подобная ситуация может случиться при использовании Geotrichum candidum и Penicillium candidum. Такое поведение бактерий является нормальной реакцией на активной рост РС.
GEO постепенной отмирает, приобретая розоватый оттенок и уступая место другому типу плесени.
Дополнительных мер для улучшения качества сыра в данной ситуации применять не требуется. Со временем РС покроет массу плотной белой коркой.
Голубая плесень
Penicillium roqueforti нельзя использовать в диком виде. Голубая плесень, выращенная на хлебных изделиях в домашних условиях, все равно является токсичной. Для приготовления сыра безопаснее использовать искусственно выведенные лабораторные штаммы.
Слишком интенсивный запах на ранних сроках созревания
Быстро распространяющийся едкий запах на ранних этапах приготовления сыра возникает из-за лишней влаги. Избавиться от данной проблемы поможет дополнительное вымешивание сыра и сухость в емкости для созревания.
Плесень растет слишком медленно на поверхности сыра
Низкая активность бактерий PR часто сопровождается ростом других типов плесени. Вероятные причины:
- Отсутствие необходимого уровня влажности. Penicillium roqueforti плохо растет при сухом воздухе.
- Бактерии Penicillium roqueforti неактивны из-за просроченного срока годности.
- Нехватка жидкости в структуре сырной массы. Чтобы избежать подобного, следует нарезать сыр более крупным кусками и тщательнее перемешивать.
Следует учесть, что данный тип плесени крайне живуч. Проблема низкой активности бактерий возникает крайне редко.
Плесень не распространяется по телу сыра
Порой бактерии прорастают очагами, из-за чего нарушается мраморная структура сыра. Причины подобного явления:
- Продукт не дозрел. Механическое нарушение структуры сыра раньше 2 месяцев приведет к гибели плесени.
- Слишком плотная структура. Отсутствие отверстий в сыре не позволяет бактериям развиться. Чтобы избежать данной ситуации, не стоит сильно прессовать заготовку.
- Отсутствие вентиляции. PR не способна развиваться в замкнутом пространстве. Для обеспечения притока воздуха следует пробить дополнительные отверстия в теле сыра с помощью игл.
Промежутки в сырной массе также часто забиваются Penicillium roqueforti . Рекомендуется наносить дополнительные отверстия каждые две недели созревания сыра.
На поверхности растет белая плесень, подавляя рост голубой плесени
Подобная ситуация случается, если условия созревания больше подходят штамму белой плесени. При низкой температуре и сухом воздухе PC вытеснить бактерии голубой плесени. Подобное также случается, если разные типы сыров хранятся в одном месте.
Чтобы избежать подобного, следует повысить влажность до 95% и температуру до 14 градусов. Также необходимо убрать голубые сорта от белых.
Итог
Приготовить сыр с плесенью можно и в домашних условиях. Данная технология отличается долгим сроком созревания и особыми условиями хранения.
Чтобы лучше наблюдать за развитием бактерий, можно сфотографировать сыр на разных этапах его приготовления. Таким образом проще сравнить степень вызревания с имеющимися фото в интернете.
Как сделать плесень в домашних условиях — Строй Обзор
Содержание
- Что такое плесень
- Способы выращивания плесени
- Этапы выращивания плесени
- Как вырастить плесень быстро
- Где еще растет плесень
Актуальность.
Я задумалась, почему плесень появляется на пищевых продуктах и решила узнать, что такое плесень? Вредна ли плесень для человека? Как она образуется? Чтобы ответить на эти вопросы, я решила провести исследовательскую работу.
Введение.
Плесень и плесневые грибки скрытно сопровождают нас в течение всей истории существования человечества, а появилась она гораздо раньше самого человека. Несмотря на множество научных исследований, активное развитие микробиологии, богатый статистический опыт, плесень остается одной из загадок нашего мира, до конца не изучена и появляется каждый раз в новом качестве. Она убивает и спасает от смерти. В чистой комнате в каждом кубометре воздуха содержится до 500 спор грибов. Более крупные способны вызвать аллергию, мелкие — лёгочные заболевания, мигрень, отит, бронхит, ринит, астму. Наконец, токсины плесени способны накапливаться в организме и приводить к раку печени. Разумеется, это не тот вид грибков, которые используют при приготовлении элитных сортов сыра и вина. Разница между ними — как между поганкой и благородным белым грибом. Открывая банку варенья, где сверху появилась белёсая плёнка, или срезая с батона зеленоватый налёт, вы сильно рискуете. Такой продукт уже целиком поражён спорами плесени. Его надо сразу выбросить и постараться даже не дышать рядом с ним. Этот микровраг готов использовать малейшую оплошность, чтобы проникнуть в наш организм и постараться разрушить его.
Плесень вредная и полезная.
Плесень
«вредная» «полезная»
Вредная плесень
Полезная плесень
вызывают опасные болезни
портят пищу человека
вызывают гибель животных
некоторые виды грибков могут вызывать диатез у детей, аллергию, переходящую в астму и даже онкологические заболевания.
получено лекарство — пенициллин, губительный для бактерий
эти маленькие труженики помогают получать вина, благородные сыры
без плесени не было бы круговорота веществ на Земле.
Состав опасной плесени.
Я рассмотрела, какая бывает плесень и выяснила, что первая полезна, а вторая опасна. Хочу подробнее остановиться на опасной плесени.
Плесень — это микроскопические грибы, насчитывается свыше 300 тысяч их видов. Каждый гриб представляет собой длинную нить и, как правило, состоит из трех частей: — корень, который проникает вглубь пищи, если может, и который часто не видим невооруженным глазом; — стебель или ветви, которые видны на поверхности; — споры, образовывающиеся на концах ветвей.
Цвет плесени определяют споры. Они также разносятся по воздуху и при соприкосновении с другими предметами.
Какие продукты можно спасти от плесени
Но нет правила без исключений. Например, с салями и вяленого окорока плесень можно просто соскрести и использовать в пищу, как ни в чем не бывало. Тоже касается твердых сыров — срежьте ножом поверхность с вредной плесенью и примерно 2-3 сантиметра сыра «вглубь», выбросьте их, а сам сыр смело ешьте. Использовать, предварительно срезав те же 3 сантиметра, можно и твердые овощи вроде капусты, моркови или картофеля.
Ученые и плесень.
Беспорядок в лаборатории Флеминга сослужил ему службу. В 1928 году он обнаружил, что на агаре в одной из чашек Петри с бактериями Staphylococcus aureus выросла колония плесневых грибов. Колонии бактерий вокруг плесневых грибов стали прозрачными из-за разрушения клеток. Флемингу удалось выделить активное вещество, разрушающее бактериальные клетки, — пенициллин, работа была опубликована в 1929 году. Флеминг не ожидал, что получить пенициллин в чистом виде будет настолько трудно. Его работу продолжили Говард Флори и Эрнст Борис Чейн, разработавшие методы очистки пенициллина. Массовое производство пенициллина было налажено во время Второй мировой войны. В 1945 году Флеминг, Флори и Чейн были удостоены Нобелевской премии в области физиологии и медицины.
Плесень — MUCOR.
Му́кор (лат. Mucor), также белая плесень — род низших плесневых грибов класса зигомицетов, который включает около 60 видов. Широко распространены в верхнем слое почвы, также развиваются на продуктах питания и органических остатках. Некоторые виды вызывают болезни (мукоромикозы) животных и человека, другие используются для получения антибиотиков или в качестве закваски (так как некоторые мукоровые грибы обладают высокой ферментативной активностью). Мицелий не поделён перегородками и представлен одной гигантской многоядерной разветвлённой клеткой.
Практическая работа №1
Тема: Выращивание плесени мукор в домашних условиях.
Цель: Я хочу сама увидеть, как плесень появляется и растет на пищевых продуктах.
Ход работы:
Выращивание плесени на хлебе.
Заражение тыквы плесенью.
Наблюдение процесса роста плесени.
Рассмотрение плесени под микроскопом.
Еще в прошлом учебном году, мой педагог Ангелина Николаевна, предложила мне провести эту исследовательскую работу на овоще. С помощью бабушки за летние каникулы я вырастила тыкву.
Затем я убрала несколько кусочков хлеба в пакеты и убрала их в тёмное место на кухне.
Через неделю на них образовалась плесень.
Следующий мой шаг состоял в заражении тыквы плесенью. Надев перчатки, я проделала ножом небольшое отверстие в тыкве. Плесенью, находящейся на хлебе, я потерла о срез в тыкве и оставила на неделю.
Через неделю срез выглядел так.
Я разрезала тыкву на куски.
Через неделю тыква выглядела так.
Я увидела, что появился маленький пушок; Через четыре дня волосинки стали больше. На них стали видны чёрные шарики, образовались пятна плесени. Через шесть дней пятна плесени увеличились и стали черного цвета.
Прошло две недели.
Через три недели.
Я рассмотрела плесень под микроскопом.
Вывод: Я проводила свою исследовательскую работу 37 дней, + времени на её подготовку.
Мне самой в домашних условия удалось вырастить плесень — мукор. Я внимательно рассмотрела её под микроскопом.
Я пришла к выводу:
Для развития плесени необходимы влажность, тепло, отсутствие проветривания. Чем выше температура воздуха, тем появление и развитие плесени происходит быстрее. Сухость воздуха и низкая температура являются главными препятствиями для развития плесени. Проведя опыты, я могу смело сказать, что плесень появляется, если имеются такие факторы как тепло, влага и нет проветривания. Плесневые грибы опасны для здоровья человека.
Заключение.
Плесень — это микроскопические грибы, насчитывается свыше 300 тысяч их видов. Каждый гриб представляет собой длинную нить и, как правило, состоит из трех частей — корень, который проникает вглубь пищи, если может и который часто невидим невооруженным глазом; — стебель или ветви, которые видны на поверхности; — споры, образовывающиеся на концах ветвей.
Выполняя данную исследовательскую работу, мною было изучено много литературы, содержащей информацию по данной теме. В ходе выполнения экспериментальной части работы было доказано, что скорость возникновения плесени зависит от следующих условий: от влажности воздуха и от температуры окружающей среды, от продуктов на которых растет плесень. Я выяснила значение плесени для здоровья человека и влияния её на экологию жилища.
Рекомендации
Закрывайте готовую пищу пленкой, чтобы защитить ее от спор плесени из воздуха. Выкладывайте скоропортящуюся пищу из открытых консервных банок в чистые контейнеры и немедленно ставьте их в холодильник. Не оставляйте скоропортящиеся продукты вне холодильника более, чем на два часа. Храните остатки пищи не более, чем 3-4 дня, чтобы плесень не успела вырасти.
Как обращаться с заплесневевшими продуктами?
Не давайте плесени шанс.
Не покупайте много продуктов и не храните их подлогу.
Но если что-то все же заплесневело? Не нюхайте заплесневелый продукт! Это может вызвать респираторные заболевания.
Если продукт питания весь покрыт плесенью – выбросите его, предварительно завернув его или поместив в маленький пластиковый пакет.
Выбрасывайте! заплесневелые продукты только в закрывающиеся мусорные контейнеры.
Немедленно вымойте холодильник или шкафчик, где находился заплесневелый продукт.
Проверьте находившиеся вблизи продукты. Плесень моментально распространяется на овощах и фруктах.
Список использованных источников и литературы
1.Кудряшова А.А., Дедюхина В.П. Микробиология, санитария и гигиена: Изд-во ДВГАЭУ, 2003.
2.Работнова И.Л., Общая микробиология, М., 2001г.
3.Исмаилова С. Энциклопедия для детей т. 2 Биология. М Аванта+, 1995г.
Наглядные опыты на уроках биологии помогают ученикам быстрее усвоить знания и получить от занятия максимальную пользу. Но, кроме того, это очень интересно и увлекательно. Очень часто преподаватели задают ученикам провести лабораторную работу по выращиванию плесени и фиксировать каждый из ее этапов.
Чтобы правильно вырастить грибок в домашних условиях, понадобиться минимум затрат и максимум терпения. Хоть процесс это и не долгий, но всем нам хочется быстрее увидеть результат.
Что такое плесень
Что представляет собой плесень и откуда она берется на хлебе. Предмет нашего изучения – это не что иное, как грибок, который приживается в теплой среде и растет на продуктах и или во влажных местах.
Плесень бывает двух видов: токсичная и не токсичная. Первая опасна для здоровья, и если ее случайно проглотить или вдохнуть, то она вызовет тошноту, рвоту, понос, а в отдельных случаях может повлиять на нервную систему и работу мозга. Вторая, напротив, является лечебным средством и применяется в народной и традиционной медицине.
Ту плесень, которую мы наблюдаем на продуктах в холодильнике, нельзя есть. Если вы случайно откусили и проглотили испорченный продукт, сразу же примите активированный уголь и запейте большим количеством воды.
Споры плесени разносятся воздухом, и, попадая в благоприятную среду, начинают активно размножаться. Они любят влажную древесину, бумагу, клей, штукатурку, продукты. Если помещение, куда попали споры, плохо проветривается, то ее будет сложно вывести.
Способы выращивания плесени
Все, что нужно для активного роста грибков, это влажный воздух и питание. В нашем случае в качестве пищи будет хлеб. Делать эксперимент можно несколькими способами, но мы рассмотрим 2 самых простых и наиболее наглядных из них.
Как вырастить плесень:
- Возьмите блюдце, положите на него кусок бумаги или натуральной ткани и сбрызните несколькими каплями воды. Сверху поместите кусок хлеба (лучше белого, так за плесенью будет легче наблюдать). Накройте блюдце пищевой пленкой или положите его в пакет и завяжите.
Каждый день добавляйте на хлеб несколько капель воды. Спустя 3-4 дня появиться сначала белая, а потом зеленая плесень.
- Возьмите стеклянную банку и поместите в нее хлеб. Смочите его водой из пульверизатора и закройте крышкой. Уберите банку в темное место и каждый день наблюдайте за результатом.
Можно просто положить кусочек хлеба в пакет и завязать, но тогда его сложно будет принести в школу, не повредив целостность плесневого покрова.
Этапы выращивания плесени
Когда вы начнете эксперимент, не забывайте фиксировать на бумаге свои наблюдения. Еще лучше, если получится их сфотографировать. По мере своего роста плесень будет менять цвет и объем, захватывая все новое пространство:
- Этап первый. Спустя 2-3 дня после начала эксперимента на хлебе появятся белые пятнышки, так плесень начинает «осваиваться» на новой территории.
- Этап второй. Плесень становится зеленой. Происходит это на 3-4 сутки после помещения хлеба под пакет. Если раньше она появлялась на отдельных участках, то теперь они срастаются воедино.
Это значит, что все условия соблюдены верно.
- Этап третий. До такого состояния хлеб доводить не обязательно, можно ограничиться и первыми двумя этапами. Но если вы хотите посмотреть, что произойдет дальше, то смело ждите еще несколько дней. Плесень за это время превратиться в черные пятна, что будет указывать на то, что на ней образуются новые споры. Это важный этап жизнедеятельности грибков, от которого зависит, будут они дальше размножаться или нет.
Так как этот вид плесени токсичен, то следует соблюдать некоторые правила безопасности. Например, если вы открываете пакет или пленку, то не дышите над хлебом, чтобы споры не попали вам в организм. На руки во время опрыскивания лучше надевать перчатки, а затем тщательно их мыть.
Как вырастить плесень быстро
Весь описанный процесс занимает от 5 до 7 дней. Но что делать, если нужно вырастить плесень быстро, за сутки или двое. Это, конечно, маловероятно, но попробовать стоит. Опять же ради эксперимента:
- Грибки любят тепло, поэтому поместите хлеб над батареей или в другое место, где температура выше комнатной.
- Если у вас дома есть сыр с плесенью или испорченные продукты, подложите уже созревшие грибки на хлеб. Они приживутся довольно быстро, что значительно ускорит процесс.
- Добавьте вместо воды молоко, в такой среде плесень растет быстрее.
- Чтобы грибок вырос быстро, выводите его на покупном хлебе, желательно не первой свежести.
- Некоторые юные экспериментаторы замечали, что плесень растет быстро на бездрожжевом несладком хлебе.
Но лучше всего не оставлять домашнее задание на последний момент, а подготовить его заранее.
Где еще растет плесень
Такой, на первый взгляд, малоприятный процесс, как выращивание плесени, на деле оказывается очень увлекательным. Вы можете расширить рамки домашнего задания и попробовать развить грибок и на других продуктах:
- Овощи или фрукты. На них плесень растет совсем по-другому, она больше напоминает грибы и имеет множество различных оттенков.
- Если вы хотите поразить преподавателя уникальностью, то сделайте из овощей или фруктов пюре, добавьте в него желатина или агар-агар и поместите под пленку.
Плесень в этом случае будет иметь замысловатый рисунок и необычный цвет.
- Некоторые идут еще дальше и добавляют в желе антибиотик, чтобы в нем не развивались бактерии, и плесень могла расти беспрепятственно. Это и ускорит процесс и сделает ваш эксперимент неповторимым.
Какой из видов выращивания плесени выберете вы. Самый простой или самый необычный. Вокруг нас каждый день происходит много интересных событий, за которыми можно наблюдать и делать удивительные открытия. В любом случае, не забывайте следить за процессом и записывать полезные выводы.
А теперь от милых жучков и паучков к противной, и в то же время безумно красивой ПЛЕСЕНИ! Я уже не одну неделю выращиваю плесень и вот что из этого получилось. Насчитал 5 разных видов плесени, но всех их запечатлеть не вышло. Первое фото — прошло 2-3 дня с начала эксперимента.
Итак, первая плесень сразу бросается в глаза, она покрыла весь кусок хлеба (тёмно-зелёная). Это пенициллы. Растут медленно и колонии более плотные, как лепешки, кстати, своих соседей могут подавлять большим количеством токсинов.
Вторая плесень растёт прямо на пенициллах. Она как плотный пух, серого оттенка. О ней я ничего не знаю.
Третья плесень стелется, как пух или паутина, окутывая всю питательную среду, то есть хлеб. Она даже умудрилась распространяться по стенкам банки, не смотря на то, что питательного субстрата там нет! Честно говоря, впервые увидел эту плесень пару месяцев назад у туркменских тараканов и был очень удивлён. Это скорее всего аспергилл или триходерма, они растут очень быстро и заполняют большие территории своей рыхлой колонией, похожи часто на паутину, т.к. спор не так много на общей массе, занимают территорию в основном из-за огромной скорости роста. Можно увидеть на ней чёрные «шарики», это шляпки грибков (в принципе, то же самое что и шляпки у лесных грибов — одна и та же функция). «Шляпки» у этой плесени могут быть чёрными и белыми. Изначально вся плесень белая, когда она окрашивается — значит появились споры (окрашены именно они), риск распространения на большие территории сильно возрастает!
Четвертая плесень самая опасная из всех — желтая (название, правда, не помню уже), выделяет самый ядовитый грибной токсин — афлотоксин Б.
И наконец пятая. Аспергиллус нигер, растёт плотно и тонким слоем. Вызывает заболевания у человека и животных, часто появляется на стенах влажных помещений.
Плесень — это не игрушки и степень патогенности может быть выше и намного опаснее, тем более что может возникнуть хронический микоз кожи — избавиться от которого практически невозможно, если иммунитет плохой. Подцепить менингит криптококковый — тоже запросто, только мало кто знает, какие последствия грибкового менингита — лежать несколько недель в коме, а потом всю оставшуюся жизнь разгребать последствия повреждения мозга.
Вот, собственно, и весь эксперимент!
Что потребуется для выращивания плесени в домашних условиях:
1. Питательный субстрат — это может быть всё что угодно из вашего холодильника (хлеб, лук, яблоко и т.д.)
2. Банка, которую можно плотно закрыть. Это нужно для сохранения влаги и для вашей безопасности, в первую очередь.
3. Влажная салфетка под питательным субстратом. Я, кстати, положил вату по углам банки для более равномерного распространения влажности, но, как показала практика, это не к чему.
5. Тепло. Для высокой скорости роста поддерживайте температуру в районе 20-25 градусов С.
6. Отсутствие прямых солнечных лучей и вообще солнечного света в целом (лампочка никак не повлияет).
На самом деле всё предельно просто. Нет ничего проще, чем вырастить плесень) Удачи!
Учебные пособия по основам изготовления пресс-форм от Smooth-On, Inc.
Эти видеоролики и пошаговые фотоуроки познакомят вас с основными методами успешного изготовления пресс-форм. Эти уроки подходят для начинающих. Если вас интересует, как изготовить слепок для воспроизведения скульптурной фигуры, старинной рамы для картины, промышленного образца, архитектурной лепнины, окаменелости, кожи животного (таксидермия), текстуры куска ткани или игрушки, Вы начинаете с изготовления резиновой формы.
Фильтровать по Товар> Процесс›
- Вакуумная камера на 5 галлонов(2)
- Алюминиевый открывалка для ведер(1)
- АкваКон™(1)
- Бронзовый металлический порошок(2)
- Cast Magic™(6)
- Crystal Clear™ 202(2)
- Dragon Skin™ 10 NV(1)
- duoMatrix™ NEO(7)
- Ease Release™ 200(2)
- Ecoflex™ 00-30(1)
- EPSILON™ + отвердитель 101(1)
- Equinox™ 38 СРЕДНИЙ(1)
- Feather Lite™(3)
- FlexFoam-iT!™ 17(1)
- FlexFoam-iT!™ X(1)
- Free Form™ AIR(1)
- Светящийся червь™(2)
- Распылитель Kwikee™(1)
- Matrix Dryve™(1)
- Контейнеры для смешивания(3)
- Молд Макс™ 14NV(1)
- Молд Макс™ 20(1)
- Молд Макс™ 29NV(1)
- Молд Макс™ 30(3)
- Mold Star™ 15 SLOW(3)
- Mold Star™ 16 FAST(1)
- Mold Star™ 20T(1)
- Молд Стар™ 30(2)
- ООМОО™ 25(3)
- ООМОО™ 30(4)
- Plasti-Paste™(1)
- Plasti-Paste™ II(1)
- PMC™-121 30/СУХАЯ(1)
- PMC™-780 СУХОЙ(2)
- Стартовый набор из жидкого силикона(2)
- Замазка PoYo™(1)
- Камера давления(2)
- Rebound™ 25(2)
- ReoFlex™ 20(1)
- Sil-Poxy™(1)
- Simpact™ 60A(1)
- Simpact™ 85A(1)
- Smooth-Cast™ 300(5)
- Smooth-Cast™ 325(4)
- Smooth-Cast™ 326(1)
- Smooth-Cast™ 57D(1)
- Smooth-Cast™ 65D(1)
- Smooth-Cast™ ONYX™ FAST(1)
- Smooth-Cast™ ONYX™ SLOW(2)
- SO-Strong™(5)
- Воск Sonite™(3)
- SORTA-Clear™ 18(2)
- SuperSeal™(1)
- ТАСК™ 3(1)
- ТАСК™ 8(1)
- THI-VEX™(1)
- Универсальная смазка для пресс-форм(1)
- URE-BOND™ II(1)
- URE-FIL™ 11(1)
- УВО™(1)
- XTEND-IT™(1)
- видеоруководство(47)
- форма для заливки(7)
- вращающееся литье(4)
- Соотношение смеси 1:1(3)
- Форма для кистей(2)
- вакуум не требуется(2)
- 3D-печать(1)
- бетонный штамп(1)
- светятся в темноте(1)
- пресс-форма(1)
- силиконовая замазка(1)
видео
Чизкейк нестандартной конструкции с использованием пищевой силиконовой замазки
Хизер дает волю своему творчеству, готовя чизкейки ручной работы.
› См. статью с инструкциями
видео
Изготовление легкого, прочного полого литья методом ротационного литья Matrix Dryve™
Майло показывает, как выполнять ротационное литье полимерно-гипсового полимера Matrix™ Dryve™
› Просмотреть статью с практическими рекомендациями
видео
Как сделать праздничные свечи-снежинки с помощью силиконовой формы
Научитесь быстро и легко делать многоразовые силиконовые формы для свечей, идеально подходящие для рождественского сезона.
› См. статью с инструкциями
Загрузите нашу брошюру с практическими рекомендациями
Smooth-On создан для того, чтобы избавить вас от догадок при изготовлении гибких форм и отливок.
› См. статью с инструкциями
видео
Как сделать силиконовую форму с помощью Mold Star™ 15
Узнайте, как сделать простую силиконовую форму из жидкого силиконового каучука Mold Star™ 15.
› См. статью с инструкциями
видео
Как залить Smooth-Cast™ 300 White Liquid Plastic
Серия жидких пластиков Smooth-Cast® 300 представляет собой литейные смолы со сверхнизкой вязкостью, которые позволяют получать отливки ярко-белого цвета и практически без пузырьков.
› См. статью с инструкциями
видео
Как сделать простую форму для блоков с использованием силикона OOMOO™
В этом учебном видеоролике показано, как изготовить цельную форму из силиконового блока с использованием силиконового каучука OOMOO®
› См. статью с инструкциями
Как сделать цельную силиконовую форму для резки
Mold Star® 15 идеально подходит для опытных производителей пресс-форм или для начинающих.
› См. статью 9 с инструкциями0003
видео
Как сделать ножи для форм своими руками
Milo показывает, как вы можете сделать свой собственный формовочный нож, используя доступные и недорогие лезвия.
› См. статью с инструкциями
видео
Как сделать двухкомпонентную силиконовую форму с помощью Mold Star™ 15
В этом видеоролике рассказывается о технике изготовления форм из двух частей с использованием силиконового каучука.
› См. статью с инструкциями
видео
Как отливать уретановую смолу Smooth-Cast™ 325
В этом обучающем видеоролике по литью смолы мы показываем, как смешивать и заливать жидкую пластиковую смолу Smooth Cast 325.
› См. статью с инструкциями
видео
Как сделать двухкомпонентную силиконовую форму с помощью OOMOO™
Изготовление формы, подготовка модели и нанесение разделительного состава для двухкомпонентной заливки формы рассказывается в этом видео.
› См. статью 9 с инструкциями0003
видео
Как сделать силиконовую кисть на форме 3D-объекта
В этом руководстве показано, как создать кисть Rebound™ 25 на силиконовой форме фигурки
› Просмотреть статью с инструкциями
видео
Как сделать силиконовую форму для модели неправильной формы
Узнайте, как сэкономить материал и деньги, приспособив силиконовую форму к форме вашей модели.
› См. статью 9 с инструкциями0003
видео
Как сделать опорную оболочку для формы, наносимой кистью, с помощью Plasti-Paste™
Как сделать опорную оболочку для кисти на силиконовой форме с помощью затирочной пластмассы Plasti-Paste.
› См. статью с инструкциями
видео
Как сделать форму для уретановых резиновых блоков
Как построить коробку для формы, измерить, смешать и залить уретановый каучук, чтобы сделать цельную блочную форму.
› См. статью 9 с инструкциями0003
видео
Как залить жидкую пластиковую литейную смолу Smooth-Cast 300 в уретановую форму
Подготовка уретановой формы для литья, дозирования и смешивания жидкого пластика.
› См. статью с инструкциями
видео
Ротокаст полой детали с помощью Smooth-Cast™ 65D
Создание полой отливки с высокой ударной вязкостью путем вращения формы во время литья.
› См. статью 9 с инструкциями0003
видео
Как сделать полую отливку из смолы с помощью Smooth-Cast™ 57D
Использование метода литья слякоть для создания полой, ударопрочной детали.
› См. статью с инструкциями
видео
Как создать металлические и блестящие эффекты в смоле с помощью Cast Magic™
Литейная система Cast Magic®— это простой способ добавить бесконечное разнообразие ярких металлических, блестящих и цветных эффектов к вашим отливкам.
› См. статью с инструкциями
видео
Как создать эффект мрамора с помощью уретанового пластика
Создание реалистичного эффекта литого мрамора возможно с помощью жидкого пластика Smooth-Cast® 325.
› См. статью с инструкциями
видео
Ротокастинг duoMatrix — Как сделать пустотелую ударопрочную отливку
Как можно использовать систему duoMatrix NEO и рубленое волокно для создания прочной, легкой и полой отливки.
› См. статью с инструкциями
видео
Как сделать металлическое холодное литье со смолой Smooth-Cast™ 325
Процесс холодного литья металла быстрее и намного дешевле по сравнению с литейным литьем расплавленного металла.
› См. статью с инструкциями
видео
Как снять крышку с 1-галлонного ведра
Одногаллонные ведра Smooth-On легко открыть, если знать правильную технику.
› См. статью с инструкциями
видео
Как открыть и разлить 5-галлонное ведро с материалом
Правильное открытие и разлив из 5-галлонного ведра приведет к меньшему количеству отходов материала.
› См. статью с инструкциями
видео
Как пользоваться алюминиевым открывалкой для ведер
Алюминиевый открывалка для ведер открывает и повторно запечатывает пластиковые ведра на 1 галлон и 5 галлонов.
› См. статью 9 с инструкциями0003
видео
Как улучшить качество поверхности отливок из пенопласта с помощью противодавления
Узнайте, как противодавление приводит к более плотной ячеистой структуре и улучшению отливок из пенопласта
› Просмотр статьи с практическими рекомендациями
видео
Как восстановить порванную силиконовую щетку на пресс-форме
Как использовать силиконовый клей Sil-Poxy® со специальной армирующей тканью для ремонта разорванного вкладыша формы.
› См. статью 9 с инструкциями0003
видео
Как отремонтировать порванную форму из уретановой резины
Ремонт разорванной формы из уретанового каучука с использованием уретанового клея Ure-Bond® II.
› См. статью с инструкциями
видео
Как воссоздать старинную раму с помощью Mold Max™ 29NV Силикон без вакуума
Узнайте, как использовать Mold Max 29NV для создания высокодетализированной силиконовой формы
› См. статью с инструкциями
видео
Как слепить опорный щит для косплея
Джон Н. показывает нам, как он создает форму для своего щита Thundercats.
› См. статью с инструкциями
видео
Заливка бетона с использованием разделительного состава Aquacon®
AquaCon® — это разделительная смазка для бетона на водной основе, помогающая отделять бетонные отливки из резиновых форм Smooth-On.
видео
Как сделать бетонный штамп с использованием уретанового каучука
Цель проекта: превратить заброшенный служебный вход в уютную пешеходную дорожку из штампованного бетона.
› См. статью с инструкциями
видео
Как использовать штамп для бетона
Проект: Замена существующего служебного входа декоративной бетонной дорожкой.
› См. статью с инструкциями
видео
Как сделать холодное литье металла с помощью duoMatrix™ NEO
Мы демонстрируем, как создать холодное литье металла с использованием полимеризованной гипсовой системы duoMatrix™ NEO.
› См. статью с инструкциями
видео
Как сделать простую силиконовую форму для свечи
Силиконовая резина OOMOO®— одна из самых простых в использовании формованных резин на планете, она идеально подходит для изготовления простых форм для свечей.
› См. статью с инструкциями
Как построить горячую печь для термоотверждаемых материалов
Мы придумали способ легко построить дешевый «горячий ящик» любого размера…
› Просмотр статьи с практическими рекомендациями
видео
Как устранить пузыри в отливках из смолы путем литья под давлением
Пузырьки в прозрачных отливках можно удалить с помощью техники литья под давлением, как показано в этом обучающем видео.
› См. статью с инструкциями
видео
Как уменьшить количество пузырьков в отливках с помощью вакуумной дегазации
Прозрачная смолалучше всего работает, когда материал очищается пылесосом перед заливкой. В этом обучающем видео описаны шаги по дегазации.
› См. статью с инструкциями
видео
Сравнение UVO™ и So-Strong™
Сравните отливку, сделанную с использованием пигмента UVO™ и такого же количества So-Strong™
видео
Как продлить срок годности уретанового каучука и смолы
XTEND-IT® представляет собой сухую газовую подушку, предназначенную для продления срока годности чувствительных к влаге полиуретановых продуктов.
› См. статью с инструкциями
видео
Как пользоваться распылителем Kwikee™
Использование распылителя Kwikee™ для распыления антиадгезивов при изготовлении форм и отливок позволит вам сэкономить более 60 % по сравнению с аэрозолями.
› См. статью с инструкциями
видео
Как предварительно смешать уретановую смолу для литья — TASK™ 3
Правильное предварительное смешивание уретановой литьевой смолы важно для обеспечения правильного отверждения материала.
› См. статью с инструкциями
видео
Как предварительно смешать уретановую литьевую смолу — Feather Lite™
В этом видеоролике показано, как правильно предварительно смешать уретановую смолу Smooth-On Feather Lite…
видео
Как сделать двухкомпонентную силиконовую форму для ножа
Мы демонстрируем использование силикона Mold Star 30, платинового силикона для изготовления форм…
› Просмотреть статью с инструкциями
видео
Как смешивать уретановую смолу для литья — двойное смешивание и заливка Feather Lite™
Использование техники двойного смешивания и заливки помогает решить проблемы с несмешанной смолой.
› См. статью с инструкциями
видео
Как предварительно смешать силиконовую резину — OOMOO™ 25
Отсутствие предварительного смешивания силикона может привести к неправильному схватыванию материала…
› Просмотр статьи с инструкциями
видео
Как смешивать силиконовый каучук — двойное смешивание и заливка OOMOO™ 25
В этом видеоролике, посвященном изготовлению форм, демонстрируется техника двойного смешивания и заливки с использованием силиконового каучука 1A:1B OOMOO.
› См. статью с инструкциями
видео
Как использовать Glow Worm® для создания светящегося в темноте литья
Как лучше всего использовать фосфоресцирующий порошок Glow Worm для создания отливки из смолы, которая будет светиться в темноте до 10 часов.
› См. статью с инструкциями
видео
Как измерить силикон по весу — Mold Max® 20
Как пользоваться граммовыми весами для точного взвешивания резины, пластика и других материалов.
› См. статью с инструкциями
видео
Как дважды смешать и залить силикон Max® 14NV
Недостаточное смешивание является основной причиной того, что силиконовый каучук не затвердевает. В этом видео демонстрируется техника двойного смешивания и заливки.
› См. статью с инструкциями
видео
Как измерить уретан по весу — Simpact™ 85A
Как пользоваться граммовыми весами для точного взвешивания резины, пластика и других материалов.
› См. статью с инструкциями
видео
Дегазация силикона вакуумом — Mold Max™ 30
Как вакуумировать силикон, чтобы удалить воздух и пузырьки из готовой формы или отливки.
› См. статью с инструкциями
видео
Как вакуумировать уретановую смолу Smooth Cast™ 326
В этом видеоролике демонстрируется вакуумная дегазация Smooth-Cast 326 для удаления захваченных пузырьков.
› См. статью с инструкциями
видео
Как построить ящик для форм
Изготовление формы для изготовления форм. Короб формы служит в качестве удерживающего поля для формовочной резины.
› См. статью с инструкциями
видео
Как использовать duoMatrix NEO™ для ротационного литья
duoMatrix NEO® — это универсальная гипсовая система, модифицированная полимерами, обладающая превосходными физическими и эксплуатационными свойствами.
видео
Типы формовочной резины RTV
Изучение различных типов формовочной резины RTV, доступных для изготовления форм и литья от Smooth-On.
› См. статью с инструкциями
видео
Условия изготовления форм и литья
Общие термины и определения в процессах изготовления форм и литья Smooth-On.
› См. статью с инструкциями
видео
Как сделать силиконовую форму для 3D-печати
В этом видео показано, как использовать Mold Star 20T для изготовления силиконовой формы из экструдированного PLA.
› См. статью с инструкциями
видео
Как формовать и отливать реквизит из пенопласта — через Tested.

Via Tested — Как сделать простые силиконовые формы для отливки и покраски пенопластовых копий реквизита, таких как магазинные инструменты
› См. статью с практическими рекомендациями
видео
Как сделать металлическую отделку с помощью порошка Cast Magic™
Как использовать порошок Pearly Green Cast Magic® на отливке из черной смолы ONYX®, чтобы получить красивую металлическую отделку.
› См. статью 9 с инструкциями0003
видео
Как восстановить старинную фоторамку с помощью замазки PoYo
Как использовать силиконовую замазку PoYo Putty для ремонта поврежденной рамы картины
› См. статью с инструкциями
видео
Изготовление безопасных для пищевых продуктов силиконовых форм — Как сделать форму для леденцов
Как сделать форму для самостоятельной заливки леденцов
› См. статью с инструкциями
видео
Как открыть застрявшую крышку контейнера
Milo показывает, как можно легко снять застрявшие крышки и предотвратить их прилипание в будущем.
› См. статью с инструкциями
видео
Изготовление пресс-формы из двух частей с помощью Mold Star™ 16
Поклонник Smooth-On Виктория П. демонстрирует, как она делает двухкомпонентный слепок глянцевой фигурки.
› См. статью с инструкциями
видео
Окрашивание duoMatrix™ NEO с использованием порошкообразных пигментов Buddy Rhodes Pure Collection
Порошкообразные пигменты Buddy Rhodes Pure Collection могут придать гипсу, модифицированному полимером duoMatrix NEO, яркие цветовые эффекты.
› См. статью с инструкциями
видео
Как создать бронзовую отделку с помощью порошков Cast Magic™ и duoMatrix™ NEO
ПорошкиCast Magic могут придать полимерно-модифицированному гипсу duoMatrix NEO потрясающий металлический, перламутровый или блестящий вид.
› См. статью с инструкциями
видео
Как устранить поверхностные пузыри в отливке
Milo демонстрирует, как можно использовать камеру высокого давления для получения отливок без пузырьков.
› См. статью с инструкциями
видео
Как сделать опорную оболочку из duoMatrix™ NEO
Milo демонстрирует, как можно использовать duoMatrix NEO для создания опорных оболочек пресс-формы.
› См. статью с инструкциями
видео
Как использовать порошки Glow Worm™ со смолой, резиной, пеной и другими материалами
Изучите различные методы заливки смолы цветом и отделки с помощью наших светящихся в темноте порошков Glow Worm™.
› См. статью с инструкциями
видео
Живи! — Литье силикона с Milo
Milo демонстрирует, как отливать силикон, и объясняет, как правильно выбрать материал формы для вашего применения.
› См. статью с инструкциями
Как сделать силиконовые формы для смолы – пошаговое руководство
Этот пост может содержать партнерские ссылки. Мы можем получать небольшую комиссию от покупок, сделанных через них, без каких-либо дополнительных затрат для вас.
Для изготовления красивых отливок или украшений из эпоксидной смолы необходимо использовать хорошую негативную форму. Они доступны в многочисленных проектах, чтобы купить. Если же вы хотите отважиться на особенные, индивидуальные формы или просто хотите что-то построить сами, то силиконовую форму можно сделать без особых усилий. В этой статье мы покажем вам, как сделать силиконовые формы для смолы своими руками.
Содержание
- 1 Работа с эпоксидной смолой
- 2 Какая эпоксидная смола лучше всего подходит для силиконовых форм?
- 3 Почему силиконовые формы являются лучшим выбором для литья смолы?
- 4 Наиболее важный фактор для форм из смолы: степень твердости
- 5 Как сделать силиконовые формы с помощью шаблона
- 6 Как сделать силиконовые формы без шаблона
- 7 Как сделать формы из смолы – некоторые соображения перед началом работы
- 8 Материалы, необходимые для изготовления силиконовых форм для смолы
- 8.
1 Лучшие наборы для изготовления силиконовых форм Рекомендации
- 8.2 Другие материалы, необходимые для изготовления собственных форм для смолы
- 8.
- 9 Как сделать силиконовые формы для смолы – шаг by Step Tutorial
- 9.1 Изготовление каркаса
- 9.2 Смешивание силикона
- 9.3 Заливка силикона
- 9.4 Извлечение готовой формы для литья силикона
- 10 Изготовление двухкомпонентных форм из смолы и силикона
- 11 Силиконовые формы с подрезами
- 12 Силиконовые формы для смолы – полезные советы и рекомендации
- 13 Как чистить формы – Учебное пособие
- 14 Как предотвратить проблемы с силиконовыми формами 9000 9000 080 9000 15 Рекомендации по изготовлению силиконовых форм своими руками
Работа с эпоксидной смолой
Для работы с эпоксидной смолой основными требованиями являются смола и соответствующий отвердитель . В зависимости от того, какому проекту вы хотите посвятить себя, будут добавлены другие материалы, такие как различные цветовые пигменты. Часто также необходимы полированные силиконовые формы. Практически нет ограничений для творчества, когда дело доходит до формовки: кубики, шары, пирамиды, звезды, сердца, цветы, подставки и всевозможные фигуры. Все возможно и может быть заполнено эпоксидной смолой для создания красивых произведений искусства или подарков.
В выбранной вами форме вы даете готовую смесь эпоксидной смолы . Либо мы используем смесь кристально чистой, либо окрашиваем жидкими красками или пигментами. Затем вы можете добавить различные элементы, такие как блестки, камни, ракушки, цветы и т. д., если хотите. После затвердевания осторожно извлеките готовую работу из формы.
Какая эпоксидная смола лучше всего подходит для силиконовых форм?
При работе с эпоксидной смолой основными требованиями являются смола и соответствующий отвердитель. В зависимости от того, какому проекту вы хотите посвятить себя, могут быть добавлены другие материалы, такие как различные цветовые пигменты. Полированные силиконовые формы также часто необходимы, чтобы придать готовому изделию более глянцевый вид.
Креативность практически безгранична, когда дело доходит до формообразования: кубики, шары, пирамиды, звезды, сердца, цветы, подставки и всевозможные фигуры. Все возможно и может быть заполнено эпоксидной смолой для создания красивых произведений искусства или подарков.
Жидкая прозрачная пластмассовая литейная смола
Вам понадобится низковязкая литейная смола для ваших форм, так как эта смола имеет жидкую консистенцию, что позволяет ей с большим эффектом заполнять все виды форм. Эта смола была разработана специально для заливки в гипс и может быть залита слоями толщиной до 2 дюймов.
Эта смола станет кристально чистой, если не будет добавлен краситель. Эта конкретная смола особенно совместима с пигментированными порошками слюды. Вы можете смешать жидкую смолу и отвердитель в соотношении 2:1.
INCREDIBLE SOLUTIONS Deep Pour Clear Casting Resin
- Индивидуальная формула создает минимальное количество пузырьков и предотвращает появление кратеров
- Эпоксидная смола при правильном использовании и отверждении безопасна со слабым запахом
- Хорошо смешивается с пигментными порошками слюды и обеспечивает кристальную чистоту
Посмотреть на Amazon
В то время как большинство смол предлагают только короткий период времени, в течение которого с ними можно работать, у вас будет значительно больше рабочего времени, прежде чем эта смола начнет затвердевать. Это связано с его низкой экзотермической скоростью, что означает, что он выделяет меньше тепла при отверждении. Однако качество густой заливки этой смолы означает, что для отверждения может потребоваться от 36 до 48 часов.
Эпоксидная смола имеет тенденцию становиться желтой при воздействии солнечного света в результате вредных ультрафиолетовых лучей солнца. Эта смола была изготовлена с дополнительными ингибиторами УФ-излучения, чтобы противостоять воздействию УФ-излучения и предотвратить пожелтение. Этот продукт также водостойкий, почти не имеет запаха и не выделяет летучих органических соединений.
Pros
- Blemish- and water-resistant
- UV-resistant
- Low odor and zero VOCs
- Longer working time
- Very little shrinkage
Минусы
- Медленное отверждение
Выбор силиконовых форм?
Благодаря тому, что он действует как антиадгезив, силикон идеально подходит в качестве материала для литейных форм . Готовые изделия из смолы можно легко извлечь из формы после отверждения благодаря гибкости силикона.
Еще одним преимуществом является то, что силикон считается нетоксичным. Тот факт, что он используется в качестве обычного материала при производстве форм для выпечки или даже пустышек, доказывает, что этот материал совершенно безвреден. Кроме того, на сегодняшний день практически не известно об аллергии на силикон.
На рынке уже представлен очень большой выбор готовых силиконовых форм. Особенно новички в этой технике могут прибегнуть к формам для выпечки из силикона или полированным силиконовым формам, сделанным специально для работы со смолой.
Если вас интересуют готовые силиконовые формы для литья эпоксидной смолы, вот наши рекомендации:
Формы для подставок LET’S RESIN Coaster для смолы
- Включает формы сердца, круглые, эллиптические, прямоугольные и квадратные формы
- Высококачественный, мягкий и гибкий силикон с высокой прочностью на разрыв
- Очень гладкая внутренняя поверхность с антипригарным покрытием, обеспечивающая эффект стекла и легкое извлечение из формы
Посмотреть на Amazon
Формы для литья силиконовой смолы EU TENG HAO, 18 шт.
- Всего в упаковке 18 предметов. легко повреждается
Посмотреть на Amazon
Формочки для ювелирных изделий из смолы LET’S RESIN
- Стартовый набор высококачественных силиконовых форм для ювелирных изделий
- Формы для браслетов, ожерелий, сережек, подвесок и колец
- Подходит для литья и УФ-смолы, но не для покрытия смола
Посмотреть на Amazon
Однако недостатком многих таких силиконовых форм (особенно форм для выпечки) является то, что нагрузка на материал чрезвычайно велика при работе с эпоксидной смолой . Первые признаки износа, т.е. матовая поверхность, быстро видны. В результате становится все труднее удалять смолу из формы. Кроме того, как уже упоминалось, доступно множество пресс-форм. Тем не менее, они, конечно, предопределены и могут ограничивать ваше собственное творчество. Решение: Вы можете легко сделать свою собственную силиконовую форму!
Наиболее важный фактор для форм из смолы: степень твердости
Основным материалом для производства силиконовых форм является силиконовый каучук. Вы можете получить его у местного дилера. Силиконовый каучук представляет собой мягкую массу, которая очень быстро затвердевает и становится чрезвычайно эластичной. Тем не менее, силикон не является бесконечно гибким: I Если материал слишком растянут, он может легко сломаться или треснуть . Степень твердости определяет хрупкость материала.
Силиконовый каучук доступен с различной степенью твердости. Степень твердости силикона указывается в единицах Шора. Эмпирическое правило здесь таково: чем ниже значение Шора, тем выше эластичность.
- Шор от 0 до 20 : Мягкий материал с очень высокой гибкостью. Однако этот материал также относительно нестабилен.
- Твердость по Шору от 20 до 40 : Довольно стабильный материал со средней эластичностью.
- Твердость по Шору от 40 до 80 : Материал достаточно твердый и малоэластичный. Он очень стабилен в размерах, но также слегка хрупок.
Степень твердости, которую вы должны выбрать для своего проекта, зависит от того, для чего вы хотите использовать силикон. Вам также может быть легче работать с одной степенью твердости, чем с другой. Вы можете только попробовать это.
Преимущество мягкого силикона в том, что готовую работу можно легко извлечь из формы после того, как он затвердеет . Однако форма также очень неустойчива при низкой степени твердости и относительно быстро деформируется. В этом отношении с силиконовыми формами с более высоким значением Шора, конечно, сложнее обращаться, так как отливку не так просто удалить. Кроме того, необходимо следить за тем, чтобы они не сломались и не порвались во время выпуска. Однако при осторожном обращении их можно использовать очень часто из-за их высокой размерной стабильности. Потому что они практически совсем не деформируются.
Помимо степени твердости, при выборе играет роль и вязкость силикона. В зависимости от проекта вы можете выбрать толстый или тонкий силиконовый каучук.
Если вы хотите изготовить формы для шоколада или выпечки из силикона, вы должны убедиться, что используемый материал является безопасным для пищевых продуктов и термостойким. Должна быть указана термостойкость до 200°С.
Если вы хотите работать с эпоксидной смолой, бетоном или другими химическими литейными материалами, вы должны сначала убедиться, что используемый вами силикон устойчив к химическим веществам.
Если вы не уверены, соответствует ли ваш силикон вашим требованиям, прочтите спецификацию производителя или обратитесь за консультацией к своему дилеру.
Если вы хотите сделать свои собственные силиконовые формы, вы можете выбрать один из двух вариантов: негативная форма с оригинальной формой или негативная форма без оригинальной формы. Мы хотели бы объяснить различия между этими двумя вариантами более подробно ниже.
Как сделать силиконовые формы
с Шаблон Негативная форма с оригинальной формой идеально подходит для изготовления копии . Для такого проекта вам понадобится рамка. Это гарантирует, что силикон не растечется бесконтрольно после заливки. Если вы хотите построить каркас самостоятельно, ориентируйтесь на размеры объекта, который хотите воспроизвести. Так как силикон довольно дорог, эта процедура имеет смысл, чтобы не расходовать излишне много материала. Ваша самодельная рама должна быть абсолютно герметичной. Это единственный способ гарантировать, что силикон не вытечет в возможные трещины или под края во время заливки. Вместо рамки вы также можете использовать пустую пластиковую упаковку для заливки смолы .
Теперь можно поместить заготовку в рамку и подготовить силикон. Как всегда, вы должны тщательно следовать инструкциям производителя. Затем равномерно распределите смесь по раме и дайте ей затвердеть. После этого форму можно просто снять с рамы.
Как сделать силиконовые формы
без шаблона Чтобы сделать силикон пригодным для этого типа обработки, вылейте смесь в миску, содержащую смесь воды и моющего средства. Затем обложите подготовленную заготовку уже гибким силиконом. Убедитесь, что вы используете достаточную массу. Если вы слишком экономите на силиконе на этом этапе, ваша форма позже станет хрупкой и нестабильной.
Если вы хотите сделать силиконовую форму таким образом, не забывайте, что форма должна иметь отверстие на конце, через которое можно будет извлечь объект. В качестве альтернативы форму можно разрезать в какой-то момент после затвердевания.
Bilder: Van Rossen / JLORTIZ / shutterstock.com
How to make Resin Molds – Some Considerations before you start
Before you start casting the mold, you стоит подумать о вашем проекте . Например, выбор подходящей силиконовой массы зависит от характера заготовки. Заранее следует принять во внимание следующие соображения:
- На что похожа поверхность заготовки? Он очень гладкий или имеет канавки, края или орнамент? Это важно для выбора оптимальной твердости силикона.
Если поверхность заготовки неровная, следует использовать мягкий силикон, чтобы позже отливку из смолы можно было извлечь из формы. С более простой заготовкой также работает силикон с более высокой степенью твердости.
- Насколько велика и тяжела заготовка? Каким материалом потом залить форму? Эти соображения также важны при выборе правильной степени твердости. Если вы преждевременно определились с мягким материалом, вполне возможны проблемы с устойчивостью при последующей заливке формы.
Для того, чтобы сделать силиконовые формы самостоятельно, это не обязательно должен быть дорогой специальный силикон. Также можно использовать силикон для ванной, купить который намного дешевле. Специально для новичков он предлагает добраться до этой экономичной альтернативы. Так вы не будете раздражаться из-за неудачных, дорогих попыток. Однако при использовании силикона для ванной вы должны знать, что вы можете использовать его только для изготовления простых силиконовых форм.
Филигранные, подробные иллюстрации не подойдут.
Материалы, необходимые для производства силиконовых форм для смолы
Если вы хотите изготовить силиконовую форму самостоятельно, тип вашего проекта определяет точные требования к материалам. Следующий список основан на негативной форме с оригинальной формой:
Лучшие наборы для изготовления силиконовых форм Рекомендации
Ваш творческий потенциал является вашим единственным ограничением, когда дело доходит до создания собственных силиконовых форм. Если вы хотите сделать силиконовую форму самостоятельно, характер вашего проекта будет определять точные требования к материалам. Следующий список основан на создании негативной формы с помощью оригинальной формы или шаблона:
Лучшее соотношение цены и качества: НЕВЕРОЯТНЫЕ РЕШЕНИЯ Набор для изготовления силиконовых форм
Этот набор для изготовления силиконовых форм содержит два компонента, которые при объединении образуют желтый нетоксичный резиновый силиконовый материал. Продукт не имеет запаха и очень удобен в использовании. При простом соотношении смешивания 1:1 две части этого набора легко комбинируются. Вы должны тщательно перемешать компоненты вместе в течение 5 минут, после чего у вас будет еще 5 минут, чтобы отлить и придать форму силикону.
НЕВЕРОЯТНЫЕ РЕШЕНИЯ Силиконовая замазка для форм
- Изготовление собственных силиконовых форм, легкое соотношение смешивания 1:1 Нет необходимости в чашках для смешивания, палочках для перемешивания и т. д.
Посмотреть на Amazon
Этот силикон не образует пузырьков, так как любые пузырьки, которые появляются, исчезнут менее чем за два часа без необходимости дегазации или нагревания. Смесь затвердеет через 5 минут, и ее необходимо выдерживать в течение 20 минут при комнатной температуре, хотя это может варьироваться в зависимости от размера и толщины формы. Людям, которые не умеют самостоятельно делать силиконовые формы, следует остановить свой выбор на этом продукте, так как он прост в использовании и легко моется. Вы можете создавать формы для любого количества применений.
Pros
- Non-toxic
- Odorless
- Food Safe
- Easy to use
Cons
- Short working time
Выбор премиум-класса: Набор для изготовления силиконовых форм BECKLY
Этот набор силиконовых форм представляет собой продукт премиум-класса, который прост в использовании и дает результаты высочайшего качества. При простом соотношении смешивания 1:1 эту жидкость с низкой вязкостью можно смешивать и наливать с максимальной легкостью. Тонкая консистенция жидкости делает ее идеальной для захвата деталей в ваших формах.
Набор для изготовления силиконовых форм BECKLY Diamond Driven
- Очень легко смешивается: пропорция смешивания 1:1
- Жизнеспособность: ~30 минут
- Отверждение через 6 часов, идеально подходит для смолы
Посмотреть на Amazon 3
3
3 Силиконовая смесь начнет затвердевать после 30 минут жизнеспособности при комнатной температуре и потребует шести часов отверждения.
Продукт следует хранить при комнатной температуре для достижения наилучших результатов. Силикон отвердевает до фиолетовый цвет , что означает, что это не лучший выбор для добавления собственных цветов. Несмотря на высокую цену, этот продукт предлагает отличное соотношение цены и качества.
Pros
- Releases bubbles automatically
- Simple mixing ratio
- Great for complex molds with a lot of detail
- Easy to use
Минуса
- Контейнеры трудно заново запечатать
- . Невозмут для работы с
- Невозможно добавить другие материалы
. Нельзя добавить. Цифровые весы в граммах и унциях- Профессиональные цифровые весы с ЖК-дисплеем и функцией TARE
- Высокая точность с точностью до 1 г (максимальный вес 5 кг)
- Идеально подходит для взвешивания литьевой смолы и смолы для ламинирования
Посмотреть на Amazon
CCBETTER Мини-пистолет для горячего клея с 30 клеевыми стержнями
- Пистолет для горячего клея с временем прогрева от 3 до 5 минут
- Идеально склеивает металл, картон, пластик, дерево, электронику и т.
д. - 30 клеевых стержней в комплекте
Посмотреть на Amazon
BRIGHT CREATIONS Листы МДФ 1/4 дюйма
- МДФ изготовлен из древесных волокон и является прочным и простым в использовании и резке
- Эти плиты МДФ очень хорошо вырезаны без острых краев, готовы к использованию и склеиванию
- Размер каждой доски 11 x 14 дюймов
Посмотреть на Amazon
Глина для лепки Sargent Art Plastilina
- Масса для лепки EFA plast classic, белая, 3 кг
- Воздушная сушка и глина, как
- отвержденный
Посмотреть на Amazon
- чашка для смешивания
- деревянные палочки для смешивания
- силиконовый спрей
- тальк
- ватный тампон
- ватный тампон0008
- изделие для воспроизведения
Чрезвычайно важно, чтобы в процессе заливки из рамы вытекало очень мало силикона или совсем не вытекало .
Поэтому с помощью зубочистки или ватной палочки все стыки закрываются моделирующим составом и каркас максимально герметизируется.
Как сделать силиконовые формы для смолы – пошаговое руководство
На первый взгляд может показаться, что делать силиконовые формы очень сложно. С нашим пошаговым руководством даже для вас, как новичка, не составит труда сделать успешный негативный слепок.
Конструкция каркаса
- Каркас, в который будет заливаться силикон, должен быть как можно лучше герметизирован, чтобы в дальнейшем материал не вытекал из-за возможных трещин. Кроме того, рамка должна полностью закрывать заготовку.
- Опорная плита прототипа должна быть гладкой. Для этой цели подходят все гладкие материалы, кроме стекла. Это не будет отталкивать силикон, и поэтому последующее высвобождение без повреждения силикона будет практически невозможно. Лучше всего использовать гладкую плиту МДФ .
Гладко выструганная древесина также очень подходит для четырех боковых стенок, окружающих опорную плиту. Теперь приклейте боковые стороны к основанию с помощью пистолета для горячего клея. Эти боковые стенки должны выступать за вашу заготовку примерно на десять миллиметров. Стыки формы должны быть тщательно герметизированы модельным составом. Для разглаживания состава подойдут ватные палочки или зубочистки. - Когда рамка будет готова, поместите в нее заготовку. Изображаемая сторона должна быть направлена вверх. Объект можно прикрепить к опорной пластине с помощью двустороннего скотча или капли горячего клея. Закрепите заготовку достаточно хорошо, чтобы она не могла соскользнуть, когда будете заливать силиконовую массу.
Смешивание силикона
- После взвешивания необходимого количества силикона смешивают два компонента в соотношении 1:1 . Для смешивания используйте чашу для смешивания и деревянную лопаточку. Будьте осторожны, чтобы не потратить слишком много силикона.
Для этого вы можете рассчитать объем или приблизительную потребность с помощью мерной палочки. - Рекомендуется смешивать несколько небольших порций вместо одной большой порции силикона . Их легче смешивать без образования комков. Так как силикон очень жесткий, размешать его очень большое количество практически невозможно. Так что лучше разделить силикон, используя несколько маленьких чашек.
- Для выхода пузырьков в массе можно несколько раз постучать чашками дном о столешницу после перемешивания . Перед заливкой силикона в рамку следует подождать несколько минут. Это единственный способ, которым любой воздух действительно может выйти из массы.
Силиконовая заливка
- Если в качестве материала для изготовления каркаса выбрано дерево, перед заливкой силикона его необходимо тщательно обрызгать разделительной смазкой . Кроме того, вы также можете покрыть раму маслом. Но будьте осторожны: не все масла совместимы с силиконом и могут воздействовать на поверхность материала.

- Поэтому y следует заранее соблюдать инструкции производителя.
- Теперь можно заливать силиконовой массой заготовку в рамку.
- Залить силиконом большой предмет с гладкой поверхностью очень просто . Здесь жидкий силикон медленно выливается с относительно большой высоты на заготовку. Убедитесь, что он полностью закрыт массой.
- Если заготовка имеет множество кромок, углов, углов или трещин , их необходимо сначала вылить. Лучше всего это работает с очень тонкой силиконовой струей. Затем можно обрамлять остатки силикона. Эта процедура гарантирует, что все детали будут видны на следующей иллюстрации.
- Затем рама заполняется оставшейся массой, пока она не будет выступать над объектом примерно на пять миллиметров.
- Наконец, из формованного силикона следует удалить пузырьки воздуха . Для этого осторожно постучите по всем четырем сторонам рамы, чтобы вышел воздух.
Затем вы можете позволить вашей форме затвердеть.
Извлечение готовой силиконовой формы для литья
- Время отверждения силиконовой формы зависит от используемого силикона и его размера . Он может варьироваться от одного до 24 часов. Если вы хотите проверить, полностью ли затвердел силикон, вы можете аккуратно вдавить его в форму пальцем. Если вы заметили, что масса затвердела, силиконовая форма теперь освобождается от рамки. Если он был тщательно обработан смазка для форм или масло, это обычно не проблема. Для окончательного выпрямления края лучше всего использовать ножницы, ковровый нож или скальпель. №
- Чтобы сохранить эластичность силикона и сохранить его, вы можете натирать его тальком после снятия с оправы и после каждого использования.
Изготовление двухкомпонентных форм из смолы и силикона
Для литья смолы, конечно же, очень подходят двухслойные формы.
При работе с эпоксидной смолой можно создавать впечатляющие трехмерные объекты, в которые можно отливать различные материалы, такие как камни, цветы или другие объекты.
Но и для моделистов формы из двух частей, конечно, очень интересны, потому что они могут создавать разные объекты . С двухкомпонентными силиконовыми формами можно без проблем комбинировать детали разных размеров и из разных материалов. Из таких материалов, как бетон или гипс, можно создать фасады домов, ворота или опоры мостов, которые после затвердевания можно красиво покрасить и декорировать.
В дополнение к материалам, уже перечисленным выше для простой формы, вам также понадобится пластилин для лепки двухкомпонентных форм . При этом вы заполняете рамку наполовину. Затем поверхность необходимо выровнять, а углы хорошо выровнять.
Теперь вдавите половину заготовки в глину и залейте силиконом рамку. После застывания тесто и силиконовую форму снимают. Готовая силиконовая форма помещается обратно в раму.
Затем заготовка помещается в ранее сделанное углубление. Чтобы позже можно было хорошо отделить половинки формы друг от друга, теперь вы должны смазать форму вазелином, прежде чем снова заливать жидкий силикон в рамку. Этот силиконовый состав также должен хорошо затвердевать.
Силиконовые формы с поднутрениями
Силиконовые формы с так называемыми поднутрениями могут представлять особую сложность . Заготовки с поднутрениями имеют хорошо видимые выступающие углы и края, которые могут мешать при извлечении из формы. Если эти поднутрения относительно небольшие и вы используете мягкий силикон (от 0 до 20 по Шору), эти кромки не должны вызывать серьезных проблем.
Немного сложнее будет в случае с большими подрезами. В этом случае целесообразно изготовить форму из двух частей или даже из нескольких частей. В любом случае вы должны выбрать гибкую мягкую силиконовую резину и обращать особое внимание при удалении объекта, чтобы он не растягивался.
Если нет возможности снять заготовку обычным способом, можно обрезать силиконовую форму с одного края и затем снять заготовку. Полученный разрез затем можно закрыть, прикрепив к форме несколько очень тугих резинок. Это позволяет очень легко впоследствии извлечь отлитую деталь из негативной формы.
Силиконовые формы для смолы – ценные советы и рекомендации0876 .
Возьмите опорную плиту из гладкого строганного дерева, а затем поместите рамку из кирпичиков Lego, которую приклейте к плите. С этим вы абсолютно гибки в размере и форме. При герметизации и последующем заливании силикона вы действуете так же, как и в случае деревянной рамы. Оптимальная комнатная температура для сушки силикона составляет от 18° до 22° C . Если температура выше, материал может слипаться, потому что сохнет слишком быстро. Если температура в помещении ниже 18°C, процесс сушки излишне затягивается. Еще один маленький трюк, если вы не уверены, сколько силикона вам действительно нужно: соберите деревянную раму, как описано, и прикрепите заготовку к опорной плите. Теперь заполните форму рисом так, чтобы он был примерно на один сантиметр выше объекта. Так как вес риса примерно соответствует необходимому количеству силикона, вам остается только его взвесить. Важный совет в конце: Чтобы не потерять радость от вашего проекта в начале, сначала запланируйте относительно простую форму и не торопитесь с реализацией .
Постепенно можно повышать уровень сложности.
Как очистить формы – Учебное пособие
С нашими советами вы вернете силиконовую форму в идеальное состояние.
- Просто поместите нетвердую эпоксидную смолу в морозильную камеру . Холод заставляет жидкую смолу кристаллизоваться, и устраняются самые большие повреждения. Этот трюк также работает с УФ-смолой, но здесь вы должны сначала попробовать его с более длительным временем отверждения. Пожалуйста, помещайте силиконовые формы в морозильную камеру только упакованными и промаркированными. Желательно в пустой отсек. В любом случае следует избегать контакта с пищевыми продуктами.
- Теперь большую часть смолы можно легко удалить, оставив только остатки. Их лучше всего удалять с большим количеством жидкости для мытья посуды , которую вы втираете в форму в перчатках и промываете водой. Поместите форму на безворсовую ткань для просушки.
- При этом форма выглядит лучше и теоретически может быть использована снова.
Но остатки прилипнут к новой смоле. Для всех перфекционистов, которые хотят потратить еще 5-10 минут работы, теперь они прибегают к клейкой ленте. Просто используйте клейкую сторону, чтобы удалить оставшуюся смолу, пигменты и остатки блесток из формы, и она должна выглядеть как новая и готова к следующему литью смолы
Как предотвратить проблемы с силиконовыми формами
- Запрещено использовать открытый огонь в форме. Выжигание пузырьков — популярный способ избавиться от надоедливых пузырьков воздуха в смоле. Но будьте осторожны: избегайте любого контакта с силиконом. Силиконовые формы можно кратковременно нагревать до 180°С. Зажигалка достигает температуры от 800° до 1300° по Цельсию — это слишком много.
- Смешайте смолу в соответствии с инструкциями на упаковке. Даже минимальные отклонения могут привести к тому, что смола станет излишне теплой, что приведет к более быстрому старению формы.
- Используйте только цвета, подходящие для смолы.
Акриловые краски могут вызвать кипение смолы и повредить форму. - Никогда не чистите силиконовые формы губками или другими кислотными средствами.
- Можно использовать разделительные составы. Разделительные составы ухудшат отделку вашей работы из смолы, но помогут вашей силиконовой форме прослужить дольше. Наше предложение: Используйте разделительные составы только для сложных форм, которые трудно формовать, или если вы уже заметили, что качество вашей силиконовой формы ухудшается.
Силиконовые формы «Сделай сам»
Даже если у вас пока нет большого опыта в изготовлении силиконовых форм, вы все равно можете сделать небольшие украшения . Нет предела вашему творчеству. Подвески различной формы из эпоксидной смолы и встроенных материалов привлекают внимание.
Если ваш ребенок очарован вашим любимым украшением, вы можете создать красивую копию с блестящими дополнительными элементами, такими как блестящие частицы.
Если вы уже немного разбираетесь в литейных формах, примите участие в изготовлении самостоятельно отлитой шахматной партии из эпоксидной смолы . Уникальная идея подарка для любителей шахмат, когда большие усилия в конце концов окупаются.
Нет предела возможностям — вы даже можете собрать гитару с помощью собственной силиконовой формы.
Обычные силиконовые формы легко доступны на рынке . Однако, если вы хотите выпустить пар и создать действительно уникальную вещь, вам не обойтись без изготовления силиконовой формы своими руками. Просто попробуйте — с нашим руководством все может пойти не так 🙂
Как делать силиконовые формы: практическое руководство
На протяжении всей истории ремесленники использовали формы для изготовления всего, от оружия бронзового века до современных потребительских товаров.
В то время как ранние формы обычно изготавливались из камня, современная наука дала начало материалам, с которыми гораздо легче работать, например силикону.
Сегодня огромное количество отраслей промышленности полагаются на изготовление силиконовых форм. Разработчики продуктов, инженеры, производители товаров «сделай сам» и даже повара изготавливают силиконовые формы для изготовления единичных или небольших партий деталей.
В этом практическом руководстве по изготовлению силиконовых форм мы разберем все, что вам нужно знать перед тем, как начать, предоставим список предметов, которые вам понадобятся, и дадим вам пошаговое руководство по изготовлению силиконовых форм для любой тип проекта.
Информационный документ
Загрузите этот отчет, чтобы узнать о примерах использования OXO, Tinta Crayons и Dame Products, которые иллюстрируют три различных варианта силиконового литья для проектирования и производства продуктов, включая многослойное литье и литье со вставками.
Загрузить информационный документ
Силикон — отличный выбор для изготовления пресс-форм, поскольку он обладает множеством преимуществ. Вы можете легко создать индивидуальный дизайн с помощью силиконового литья. Сами формочки тоже достаточно прочные, поэтому их можно использовать многократно, не опасаясь поломки. Неорганический состав силикона — по сравнению с каучуком, его органическим аналогом — делает его очень устойчивым к теплу и холоду, химическому воздействию и даже грибку. Некоторые из преимуществ силиконовых форм включают следующее:
Гибкость силикона облегчает работу с ним. Силиконовые формы гибкие и легкие по сравнению с более жесткими материалами, такими как пластик, и их также легче удалить после того, как деталь полностью сформирована. Благодаря высокому уровню гибкости силикона как форма, так и готовая деталь с меньшей вероятностью сломаются или отколются. Вы можете использовать специальные силиконовые формы, чтобы формировать все, от сложных инженерных компонентов до кубиков льда или кондитерских изделий на праздничную тематику.
Силикон выдерживает температуру от -65° до 400° градусов Цельсия. Кроме того, он может иметь удлинение 700%, в зависимости от состава. Обладая высокой стабильностью в широком диапазоне условий, вы можете помещать силиконовые формы в духовку, замораживать их и растягивать во время извлечения.
В большинстве случаев вы получите много тиражей из силиконовой формы. Однако важно отметить, что срок службы плесени может сильно различаться. Чем чаще вы отливаете и чем сложнее или детальнее ваш дизайн, тем быстрее ваша литейная форма может разлагаться. Чтобы продлить срок службы силиконовых форм, очистите их водой с мягким мылом, тщательно высушите и храните в горизонтальном положении, не штабелируя.
Несмотря на то, что работа с силиконом имеет множество преимуществ, необходимо помнить о некоторых ограничениях:
Силикон стоит дороже, чем латекс и органический каучук. Быстрое сравнение на Amazon показывает, что стоимость галлона силикона обычно превышает 100 долларов — почти в два раза больше, чем латекса.
Несмотря на свою гибкость, силикон может порваться, если его слишком сильно растянуть.
Не все силиконы имеют одинаковый состав. Всегда покупайте силикон и любые производственные материалы у надежного поставщика.
Как любители, так и профессионалы полагаются на силиконовые формы из-за их универсальности и простоты использования. Вот несколько примеров отраслей и областей применения, которые изготавливают силиконовые формы для производства своей продукции:
Силиконовое литье используется при создании прототипов и разработке продуктов в самых разных отраслях промышленности. Поскольку стоимость силиконовых форм значительно ниже, чем стоимость жестких инструментов для традиционных производственных процессов, таких как литье под давлением, литье в силиконовые формы идеально подходит для создания прототипов изделий, а также для создания бета-моделей для тестирования рынка и реакции потребителей на новый продукт. В то время как 3D-печать лучше подходит для быстрого создания одноразовых деталей, силиконовое литье и литье из уретана идеально подходят для небольших партий деталей.
Веб-семинар
Производство мостов быстрее, чем традиционные методы производства, и полезно для продуктов, объемы которых невелики или может потребоваться изменение конструкции. Посмотрите этот вебинар, чтобы узнать, как перейти от 3D-печати к литью среднего объема и литью под давлением.
Посмотреть вебинар прямо сейчас
Ювелиры используют специальные силиконовые формы для дублирования вырезанных вручную или напечатанных на 3D-принтере узоров из воска, что позволяет им постепенно отказаться от трудоемкой работы по созданию вырезанных из воска узоров для каждого нового изделия, но при этом продолжают отлить из воска. Это предлагает значительный скачок в серийном производстве, позволяя литью по выплавляемым моделям работать в больших масштабах. Поскольку силиконовые формы обеспечивают высокий уровень детализации, ювелиры могут изготавливать изделия с богато украшенными деталями и сложной геометрией.
Силиконовая форма RTV (вулканизированная при комнатной температуре), сформированная вокруг 3D-печатного образца.
Информационный документ
3D-печать с использованием высокоэффективных материалов позволяет дизайнерам и литейщикам использовать цифровые технологии в своих производственных процессах. Прочтите сейчас, чтобы узнать, как 3D-печать можно использовать для производства мелких металлических деталей.
Загрузить информационный документ
Создатели используют силиконовые формы для изготовления множества нестандартных поделок, таких как мыло и свечи. Даже производители школьных принадлежностей часто используют силиконовые формы для изготовления таких предметов, как мел и ластики.
Например, небольшая австралийская компания Tinta Crayons использует силиконовое литье для изготовления мелков игривой формы с высокой детализацией поверхности.
Силиконовые формованные мелки от Tinta Crayons.
(Источник изображения)
Силиконовые формы для пищевых продуктов используются для изготовления всевозможных причудливых кондитерских изделий, включая шоколад, мороженое и леденцы. Так как силикон выдерживает температуру до 400 градусов по Цельсию, формы можно использовать и в кулинарии. Маленькая выпечка, такая как кексы и кексы, хорошо поднимается в силиконовых формах.
Независимые художники и мастера часто используют силиконовую лепку для создания уникальных творений. Вы можете использовать силиконовые формы, чтобы сформировать или воспроизвести что угодно, от бомбочек для ванн до лакомств для собак — возможности практически безграничны. Забавный проект по лепке из силикона для детей — создать слепок своей руки. Просто убедитесь, что вы выбрали безопасный для кожи силикон.
Шаблон, иногда называемый мастером, — это деталь, которую вы используете для создания точного негатива в силиконовой форме. Если вы просто пытаетесь воспроизвести существующий объект, возможно, имеет смысл использовать этот объект в качестве шаблона.
Вам просто нужно быть уверенным, что объект выдержит процесс изготовления формы.
Чтобы создать новый дизайн или прототип, вы должны сначала изготовить свой шаблон; у вас есть несколько вариантов для этого. Вот несколько способов изготовления лекал для силиконовой лепки:
Лепка. Если вы талантливый скульптор или создаете относительно простой дизайн, вы можете использовать глину для создания узора. Лепка по шаблону также является забавным проектом для детей и экономичным вариантом для мастеров, занимающихся своими руками.
Резьба – Вы можете сделать свой узор из дерева. Мастера по резному дереву – отличный выбор для изготовления плитки и плоских конструкций.
3D-печать. Многие профессионалы и коммерческие дизайнеры выбирают 3D-печать шаблонов. Настольные 3D-принтеры предлагают множество преимуществ, включая гибкость проектирования в рамках программного обеспечения САПР, высокую точность, простоту модификации прототипа и быстрое время выполнения работ.
Когда у вас есть шаблон, вы можете приступить к изготовлению силиконовой формы.
Информационный документ
В этом техническом документе вы узнаете, как сочетать быструю оснастку с традиционными производственными процессами, такими как литье под давлением, термоформование или литье.
Загрузить информационный документ
Образец детали
Посмотрите и почувствуйте 3D-печатный образец высокого разрешения из первых рук. Мы отправим бесплатный образец детали в ваш офис.
Запросите бесплатный образец Деталь
Вот все, что вам нужно для создания базового набора силиконовых форм:
Мастер-шаблон
Жидкий силикон, например Smooth-On OOMOO 30
Коробка или непористый контейнер для корпуса пресс-формы
Разделитель для форм, например, универсальный разделитель для форм Smooth-On
Воск, смола или другой материал конечного использования
Прежде чем приступить к изготовлению форм, вам необходимо определить, какой тип форм вы хотите создать.
Цельные силиконовые формы похожи на формочки для кубиков льда. Вы заполняете форму, а затем даете материалу застыть. Однако так же, как лоток для кубиков льда создает кубики с плоской вершиной, цельные формы будут работать только с конструкциями, имеющими плоскую сторону. Если у вашего мастера есть глубокие подрезы, это также усложняет его извлечение и готовые детали из формы после того, как силикон затвердеет без повреждений.
Если это не касается вашего дизайна, цельная силиконовая форма — идеальный способ создать бесшовную 3D-репродукцию вашего мастера на всех его других поверхностях.
Цельные силиконовые формы идеально подходят для конструкций с плоской стороной и без глубоких подрезов.
Силиконовая форма, состоящая из двух частей, лучше подходит для воспроизведения вашего 3D-мастера без плоской стороны или с глубокими подрезами. Форма разделяется на две части, которые снова соединяются вместе, образуя заполняемую трехмерную полость (аналогично тому, как работает литье под давлением).
Двухкомпонентные формы не оставляют плоских поверхностей, и с ними легче работать, чем с цельными формами. С другой стороны, их немного сложнее создать, и могут образоваться швы, если две части не будут идеально заподлицо.
Двухкомпонентные силиконовые формы позволяют воспроизвести любой мастер-дизайн. (источник изображения)
Во-первых, вам нужно решить, хотите ли вы использовать цельную или двухкомпонентную форму. Процессы изготовления этих форм аналогичны, но создание формы, состоящей из двух частей, займет немного больше времени. Вы можете использовать следующую пошаговую инструкцию, чтобы создать свои собственные силиконовые формы.
Создайте шаблон продукта: Это окончательный дизайн детали, который будет воспроизведен в другом материале. При 3D-печати на стереолитографическом (SLA) 3D-принтере используйте любой стандартный полимер с высотой слоя 50 микрон. Следите за тем, чтобы на детализированной поверхности не было следов поддержки.
Тщательно промойте детали изопропиловым спиртом — любая остаточная липкость на поверхности может повлиять на процесс литья силикона.
Изготовление корпуса формы: МДФ с покрытием является популярным выбором для изготовления герметизирующей коробки для силиконовой формы, но подойдет даже простой готовый пластиковый контейнер. Ищите непористые материалы и плоское дно.
Разложите шаблон и нанесите смазку: Начните с легкого распыления смазки на внутреннюю часть корпуса формы. Разместите шаблоны внутри коробки детализированной стороной вверх. Слегка распылите на них разделитель для плесени. Для полного высыхания потребуется около 10 минут.
Приготовьте силикон: Смешайте силиконовый каучук в соответствии с инструкциями на упаковке. Вы можете использовать вибрирующее устройство, например, ручную электрическую шлифовальную машину, чтобы удалить пузырьки воздуха.
Залейте силикон в корпус пресс-формы: Аккуратно тонкой струйкой залейте смешанный силиконовый каучук в защитную коробку.
Сначала нацельтесь на самую нижнюю часть коробки (основание) и постепенно приближайтесь к контурам вашего 3D-печатного шаблона. Покройте его хотя бы одним сантиметром силикона. Процесс отверждения занимает от одного часа до одного дня, в зависимости от типа и марки силикона.
Извлечение силикона из формы: По завершении отверждения выньте силикон из защитной коробки и извлеките шаблоны. Это послужит вашей формой в виде лотка для кубиков льда для отливки конечного продукта.
Отливка детали: Опять же, рекомендуется слегка сбрызнуть силиконовую форму смазкой и дать высохнуть в течение 10 минут. Залейте готовый материал (например, воск или бетон) в полости и дайте им застыть.
Подготовка формы для следующей отливки: Эту силиконовую форму можно использовать несколько раз. Вернитесь к шагу семь, чтобы повторить процесс.
Чтобы создать пресс-форму, состоящую из двух частей, начните с первых двух шагов, описанных выше, которые включают создание шаблона и конструирование корпуса пресс-формы.
После этого выполните следующий процесс для создания пресс-формы, состоящей из двух частей:
Выложите шаблоны из глины: Используйте глину, чтобы сформировать то, что в конечном итоге станет половиной вашей формы. Глина должна быть помещена внутрь корпуса формы так, чтобы половина мастера торчала из глины.
Подготовьте и залейте силикон: Следуйте инструкциям на упаковке силикона, чтобы подготовить и аккуратно залить силикон в корпус формы поверх глины и мастеров. Этот слой силикона будет половиной вашей формы, состоящей из двух частей.
Удалите все из корпуса формы: После того, как ваша первая форма затвердеет, вам нужно будет удалить силиконовую форму, шаблоны и глину из корпуса формы. Ничего страшного, если слои разделятся при извлечении.
Очистите глину: Очистите всю глину, чтобы открыть свою первую силиконовую форму и мастера. Убедитесь, что ваши мастера и существующая форма полностью чистые.
Поместите форму и шаблоны обратно в корпус формы: Вставьте существующую силиконовую форму и шаблоны (уложенные в форму) обратно в корпус формы лицевой стороной вверх, а не вниз.
Нанесите разделительный состав: Нанесите тонкий слой разделительного состава на верхнюю часть шаблона и существующей силиконовой формы, чтобы облегчить извлечение из формы.
Подготовьте и залейте силикон для второй формы: Следуя тем же инструкциям, что и раньше, подготовьте и залейте силикон в корпус формы для создания второй формы.
Подождите, пока затвердеет вторая форма: Подождите, пока вторая форма затвердеет, прежде чем пытаться извлечь ее из корпуса формы.
Извлеките из формы детали: Извлеките обе силиконовые формы из корпуса формы и осторожно раздвиньте их.
В конце концов, не существует единственно правильного способа производить продукты, будь то еда, фигурки или коммерческие компоненты.









Если нет возможности снять заготовку обычным способом, можно обрезать силиконовую форму с одного края и затем снять заготовку. Полученный разрез затем можно закрыть, прикрепив к форме несколько очень тугих резинок. Это позволяет очень легко впоследствии извлечь отлитую деталь из негативной формы.




Обычные силиконовые формы легко доступны на рынке . Однако, если вы хотите выпустить пар и создать действительно уникальную вещь, вам не обойтись без изготовления силиконовой формы своими руками. Просто попробуйте — с нашим руководством все может пойти не так 🙂



Силикон стоит дороже, чем латекс и органический каучук. Быстрое сравнение на Amazon показывает, что стоимость галлона силикона обычно превышает 100 долларов — почти в два раза больше, чем латекса.
Несмотря на свою гибкость, силикон может порваться, если его слишком сильно растянуть.
Не все силиконы имеют одинаковый состав. Всегда покупайте силикон и любые производственные материалы у надежного поставщика.

Лепка. Если вы талантливый скульптор или создаете относительно простой дизайн, вы можете использовать глину для создания узора. Лепка по шаблону также является забавным проектом для детей и экономичным вариантом для мастеров, занимающихся своими руками.
Резьба – Вы можете сделать свой узор из дерева. Мастера по резному дереву – отличный выбор для изготовления плитки и плоских конструкций.
3D-печать. Многие профессионалы и коммерческие дизайнеры выбирают 3D-печать шаблонов. Настольные 3D-принтеры предлагают множество преимуществ, включая гибкость проектирования в рамках программного обеспечения САПР, высокую точность, простоту модификации прототипа и быстрое время выполнения работ.
Мастер-шаблон
Жидкий силикон, например Smooth-On OOMOO 30
Коробка или непористый контейнер для корпуса пресс-формы
Разделитель для форм, например, универсальный разделитель для форм Smooth-On
Воск, смола или другой материал конечного использования


Создайте шаблон продукта: Это окончательный дизайн детали, который будет воспроизведен в другом материале. При 3D-печати на стереолитографическом (SLA) 3D-принтере используйте любой стандартный полимер с высотой слоя 50 микрон. Следите за тем, чтобы на детализированной поверхности не было следов поддержки. Тщательно промойте детали изопропиловым спиртом — любая остаточная липкость на поверхности может повлиять на процесс литья силикона.
Изготовление корпуса формы: МДФ с покрытием является популярным выбором для изготовления герметизирующей коробки для силиконовой формы, но подойдет даже простой готовый пластиковый контейнер. Ищите непористые материалы и плоское дно.
Разложите шаблон и нанесите смазку: Начните с легкого распыления смазки на внутреннюю часть корпуса формы. Разместите шаблоны внутри коробки детализированной стороной вверх. Слегка распылите на них разделитель для плесени. Для полного высыхания потребуется около 10 минут.
Приготовьте силикон: Смешайте силиконовый каучук в соответствии с инструкциями на упаковке. Вы можете использовать вибрирующее устройство, например, ручную электрическую шлифовальную машину, чтобы удалить пузырьки воздуха.
Залейте силикон в корпус пресс-формы: Аккуратно тонкой струйкой залейте смешанный силиконовый каучук в защитную коробку. Сначала нацельтесь на самую нижнюю часть коробки (основание) и постепенно приближайтесь к контурам вашего 3D-печатного шаблона. Покройте его хотя бы одним сантиметром силикона. Процесс отверждения занимает от одного часа до одного дня, в зависимости от типа и марки силикона.
Извлечение силикона из формы: По завершении отверждения выньте силикон из защитной коробки и извлеките шаблоны. Это послужит вашей формой в виде лотка для кубиков льда для отливки конечного продукта.
Отливка детали: Опять же, рекомендуется слегка сбрызнуть силиконовую форму смазкой и дать высохнуть в течение 10 минут. Залейте готовый материал (например, воск или бетон) в полости и дайте им застыть.
Подготовка формы для следующей отливки: Эту силиконовую форму можно использовать несколько раз. Вернитесь к шагу семь, чтобы повторить процесс.

Выложите шаблоны из глины: Используйте глину, чтобы сформировать то, что в конечном итоге станет половиной вашей формы. Глина должна быть помещена внутрь корпуса формы так, чтобы половина мастера торчала из глины.
Подготовьте и залейте силикон: Следуйте инструкциям на упаковке силикона, чтобы подготовить и аккуратно залить силикон в корпус формы поверх глины и мастеров. Этот слой силикона будет половиной вашей формы, состоящей из двух частей.
Удалите все из корпуса формы: После того, как ваша первая форма затвердеет, вам нужно будет удалить силиконовую форму, шаблоны и глину из корпуса формы. Ничего страшного, если слои разделятся при извлечении.
Очистите глину: Очистите всю глину, чтобы открыть свою первую силиконовую форму и мастера. Убедитесь, что ваши мастера и существующая форма полностью чистые.
Поместите форму и шаблоны обратно в корпус формы: Вставьте существующую силиконовую форму и шаблоны (уложенные в форму) обратно в корпус формы лицевой стороной вверх, а не вниз.
Нанесите разделительный состав: Нанесите тонкий слой разделительного состава на верхнюю часть шаблона и существующей силиконовой формы, чтобы облегчить извлечение из формы.
Подготовьте и залейте силикон для второй формы: Следуя тем же инструкциям, что и раньше, подготовьте и залейте силикон в корпус формы для создания второй формы.
Подождите, пока затвердеет вторая форма: Подождите, пока вторая форма затвердеет, прежде чем пытаться извлечь ее из корпуса формы.
Извлеките из формы детали: Извлеките обе силиконовые формы из корпуса формы и осторожно раздвиньте их.
